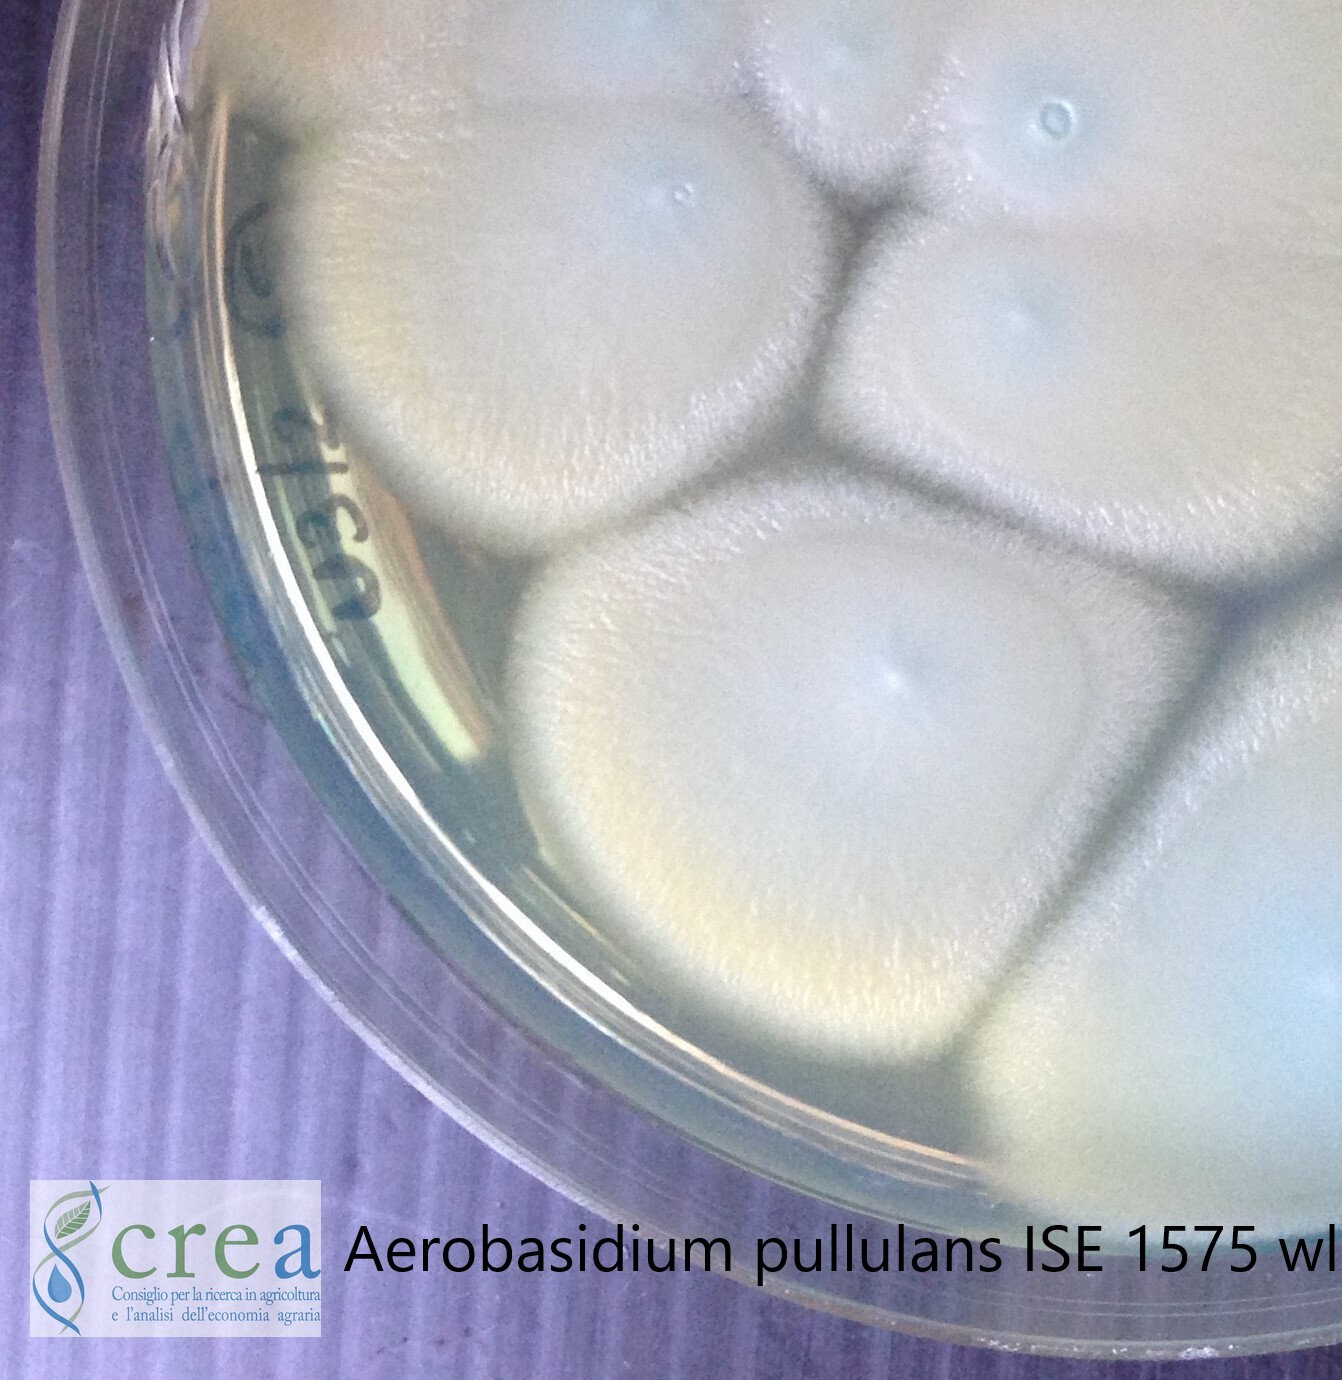
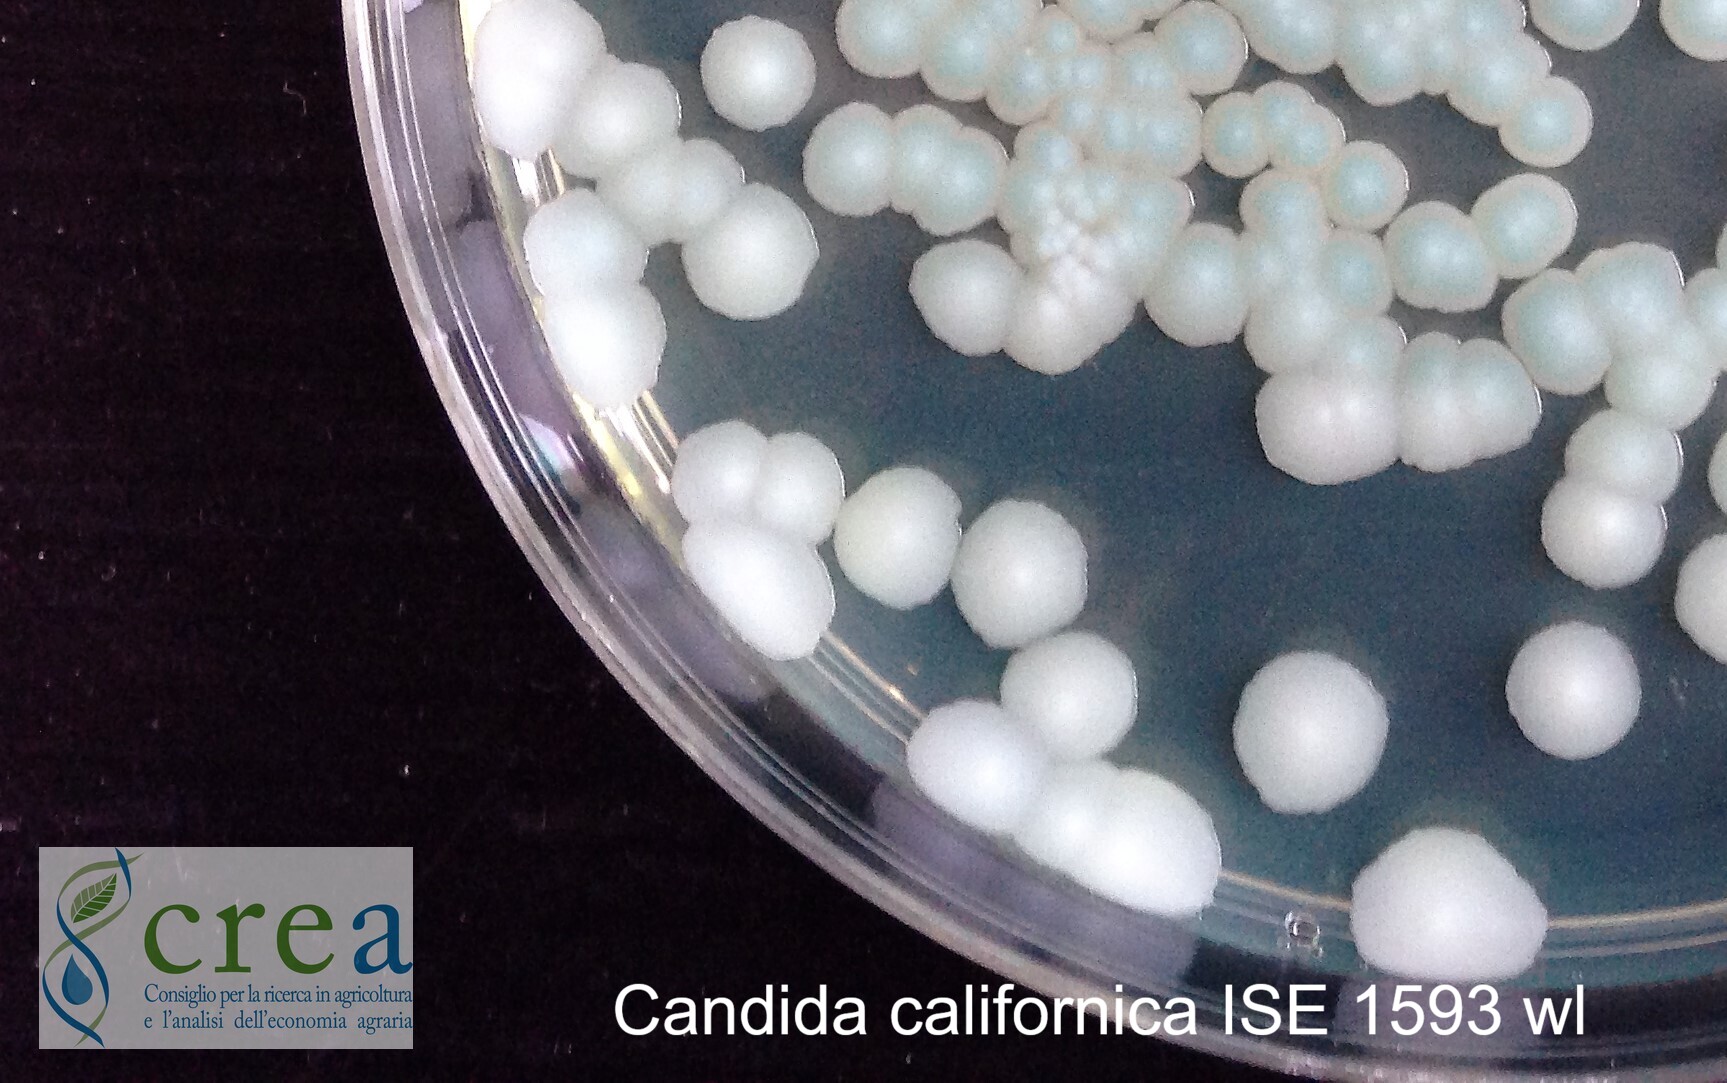
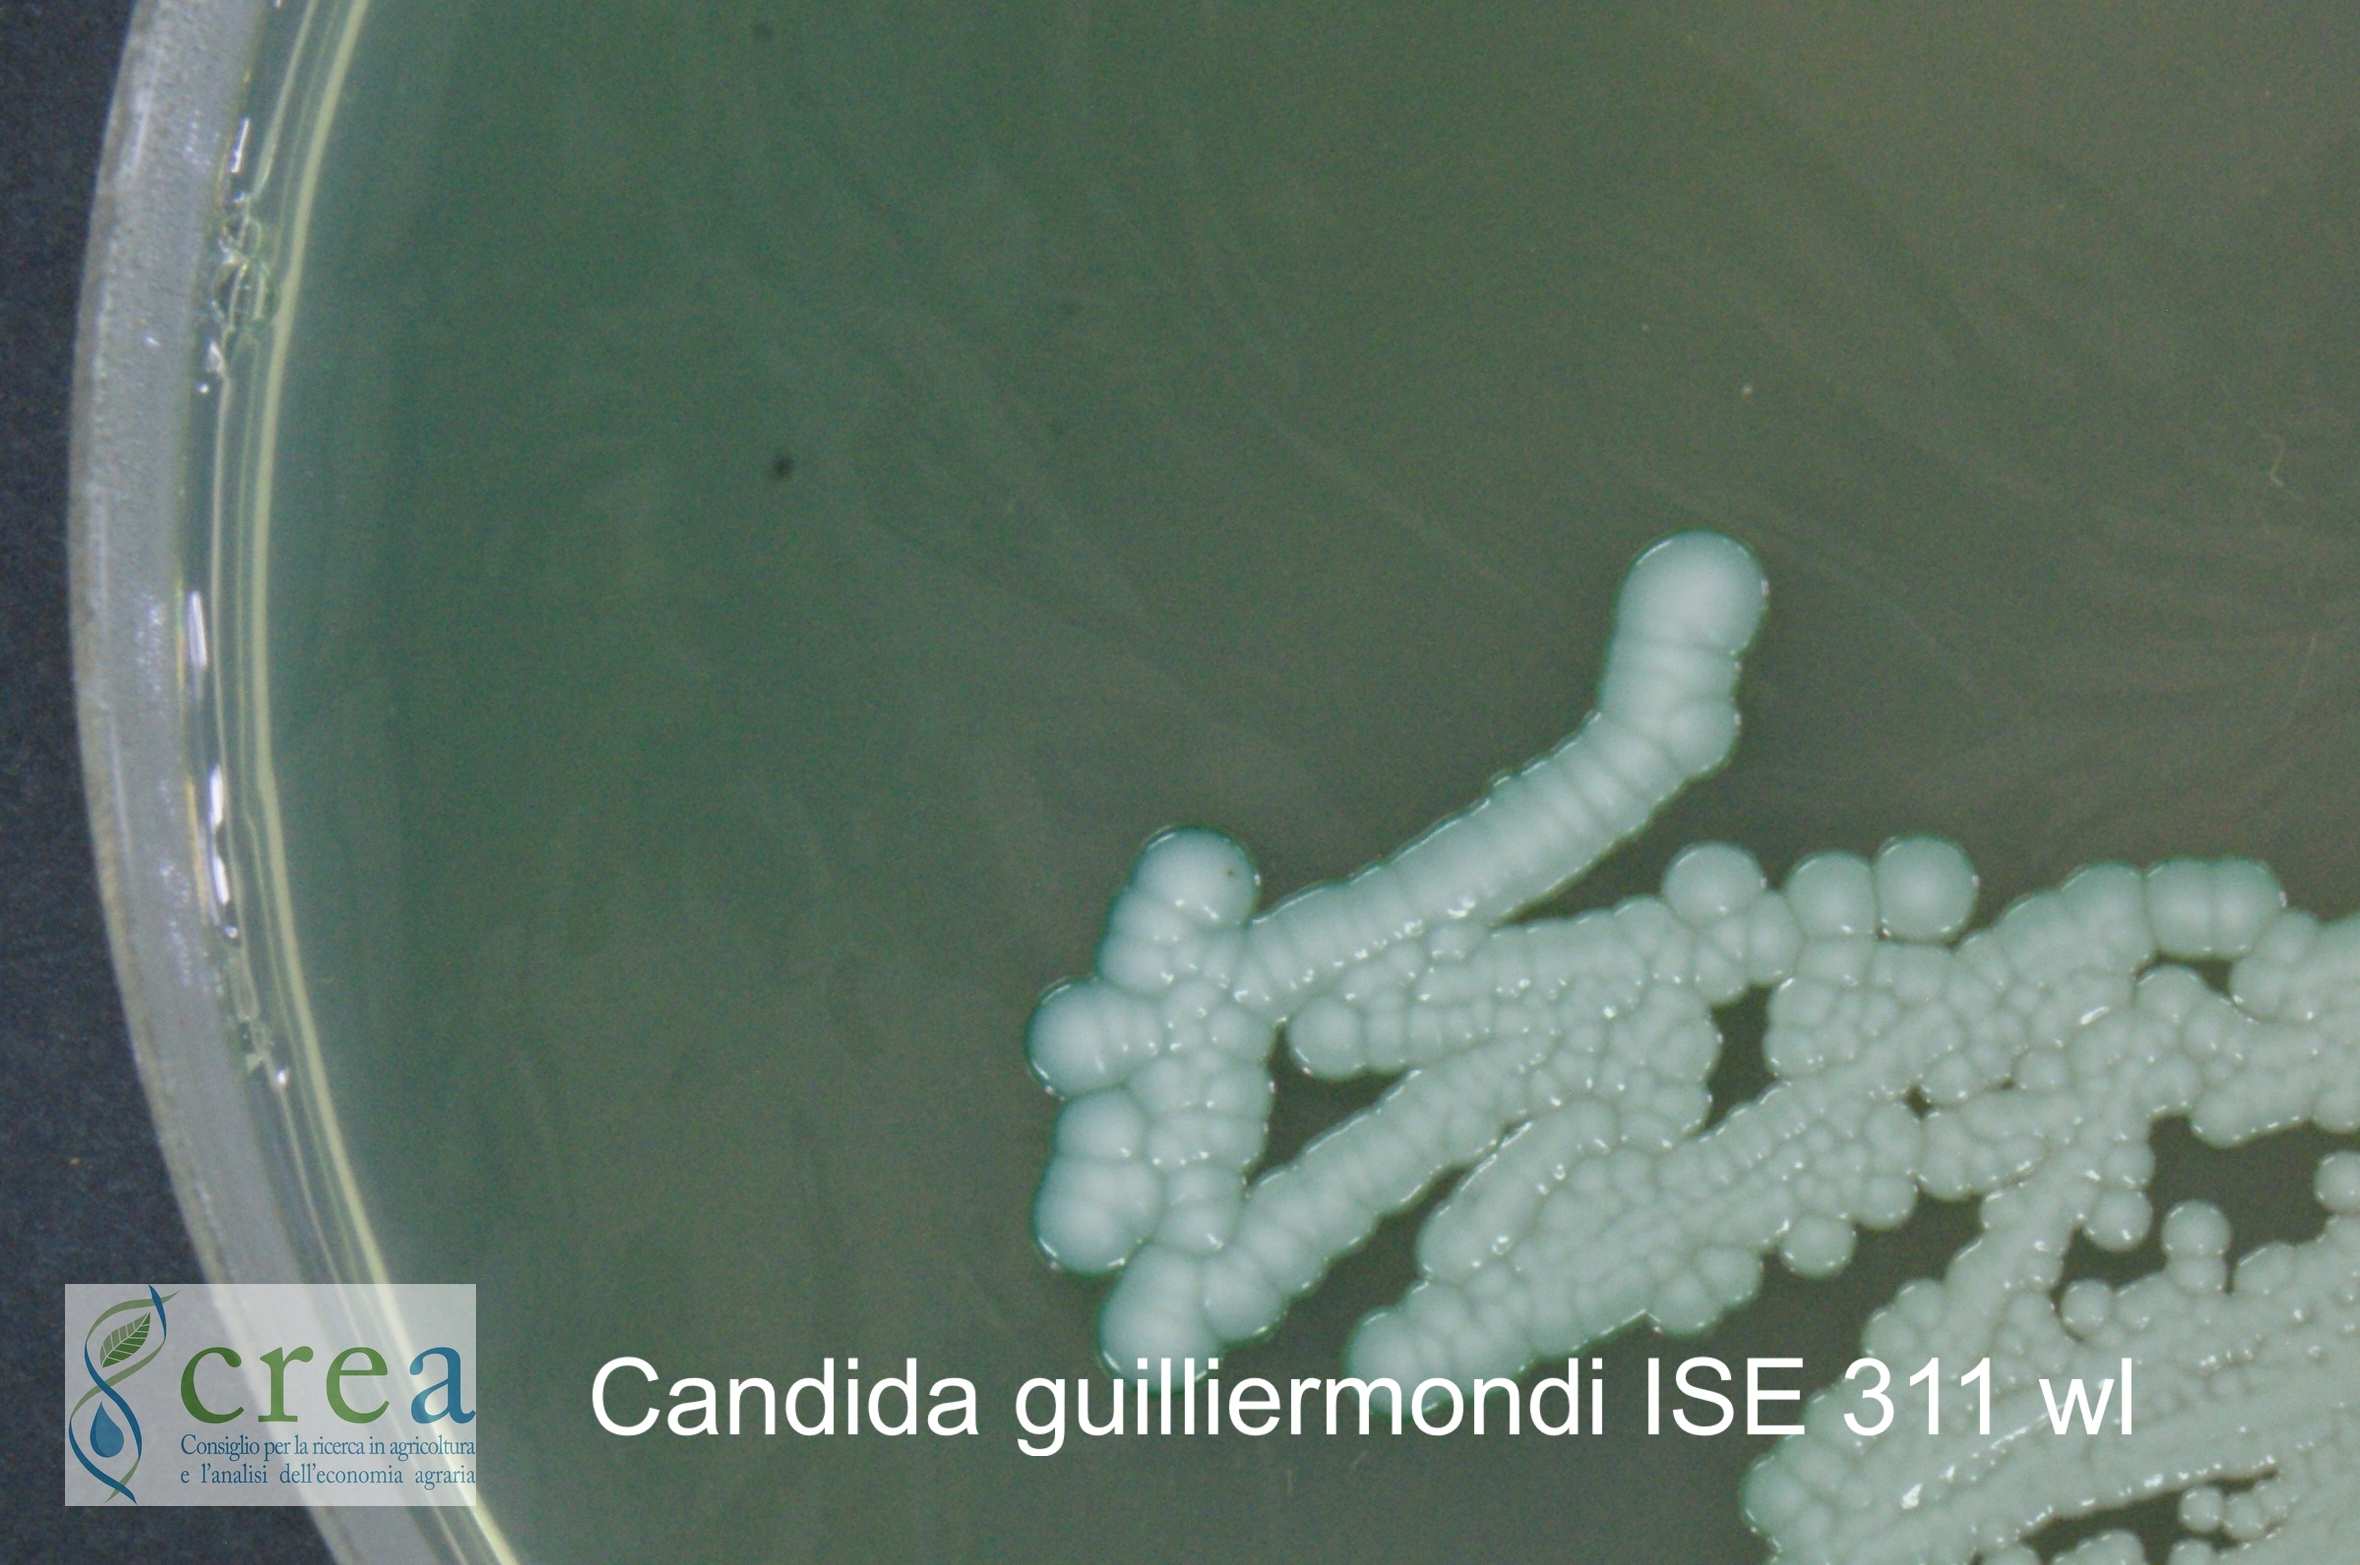
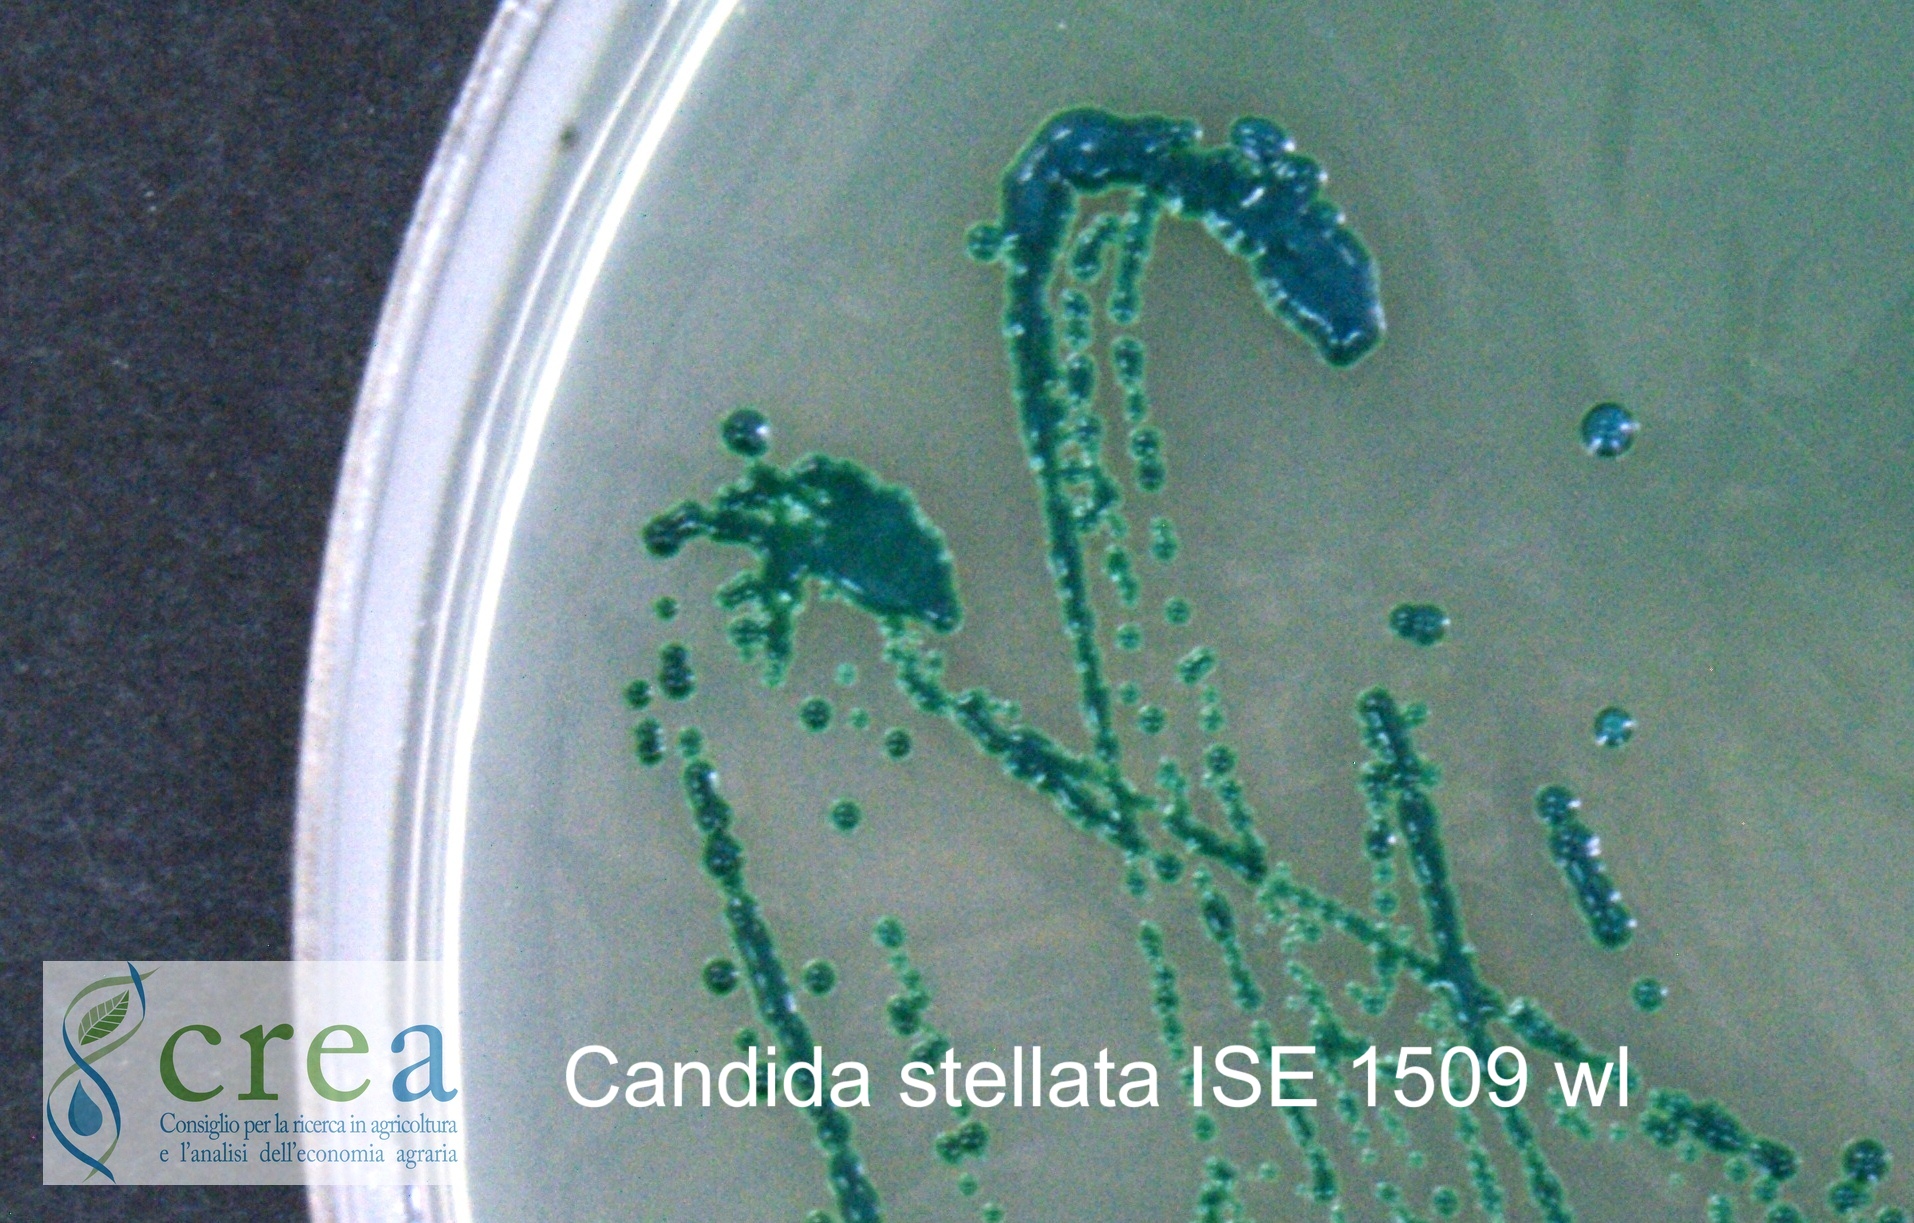
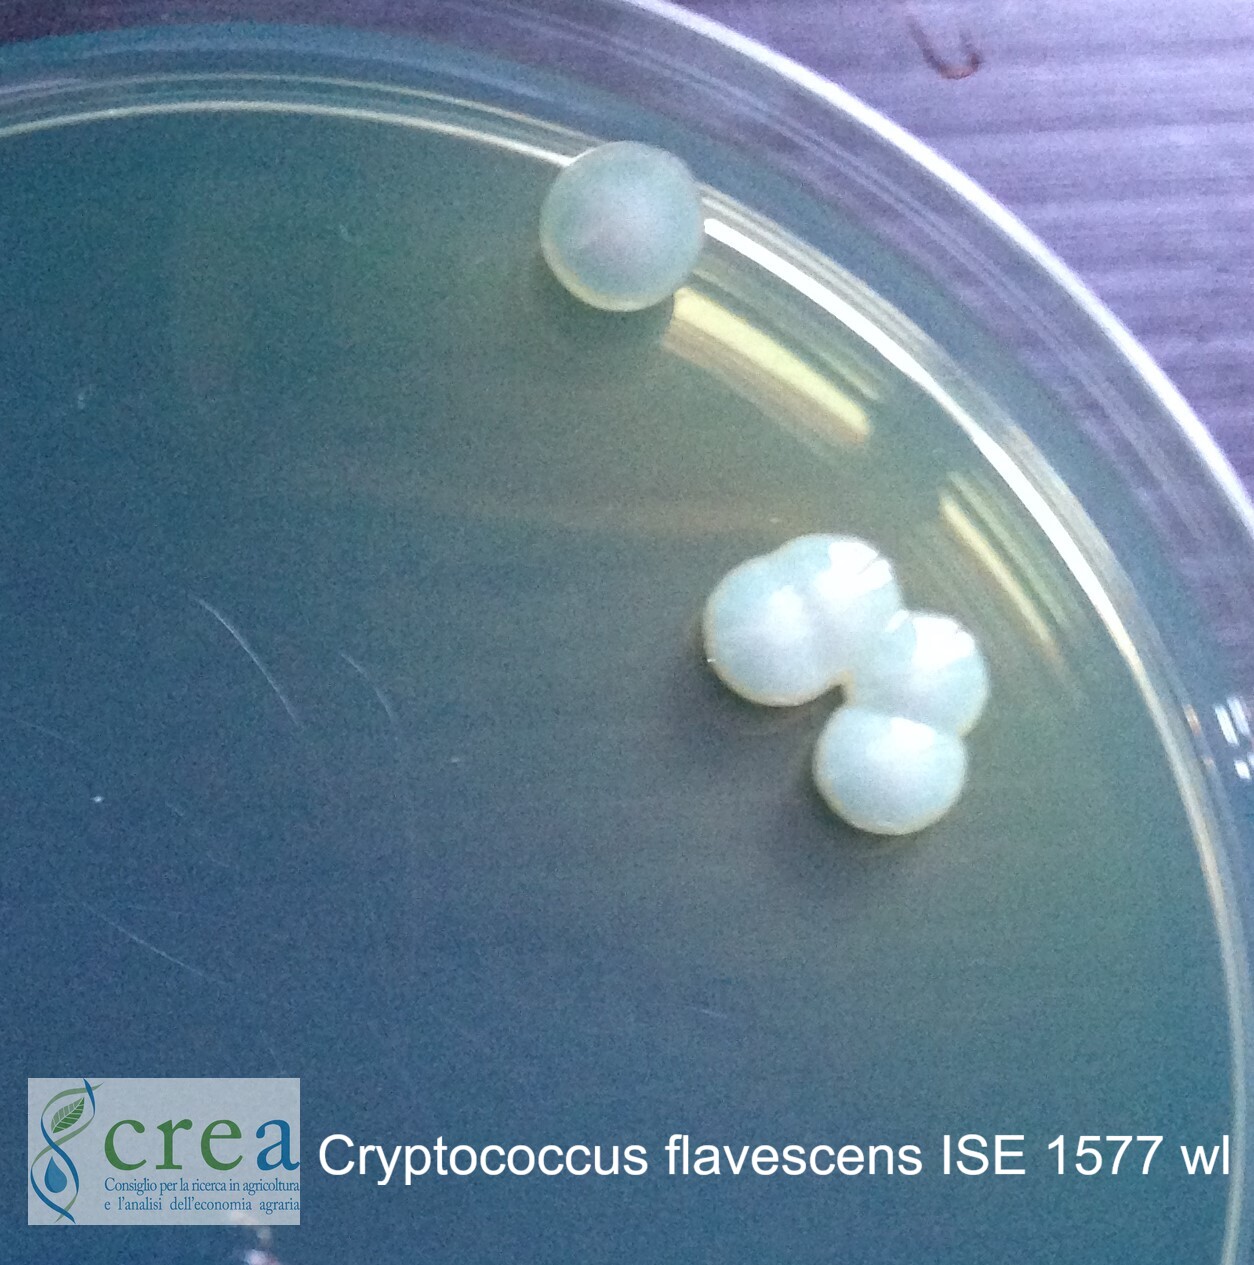
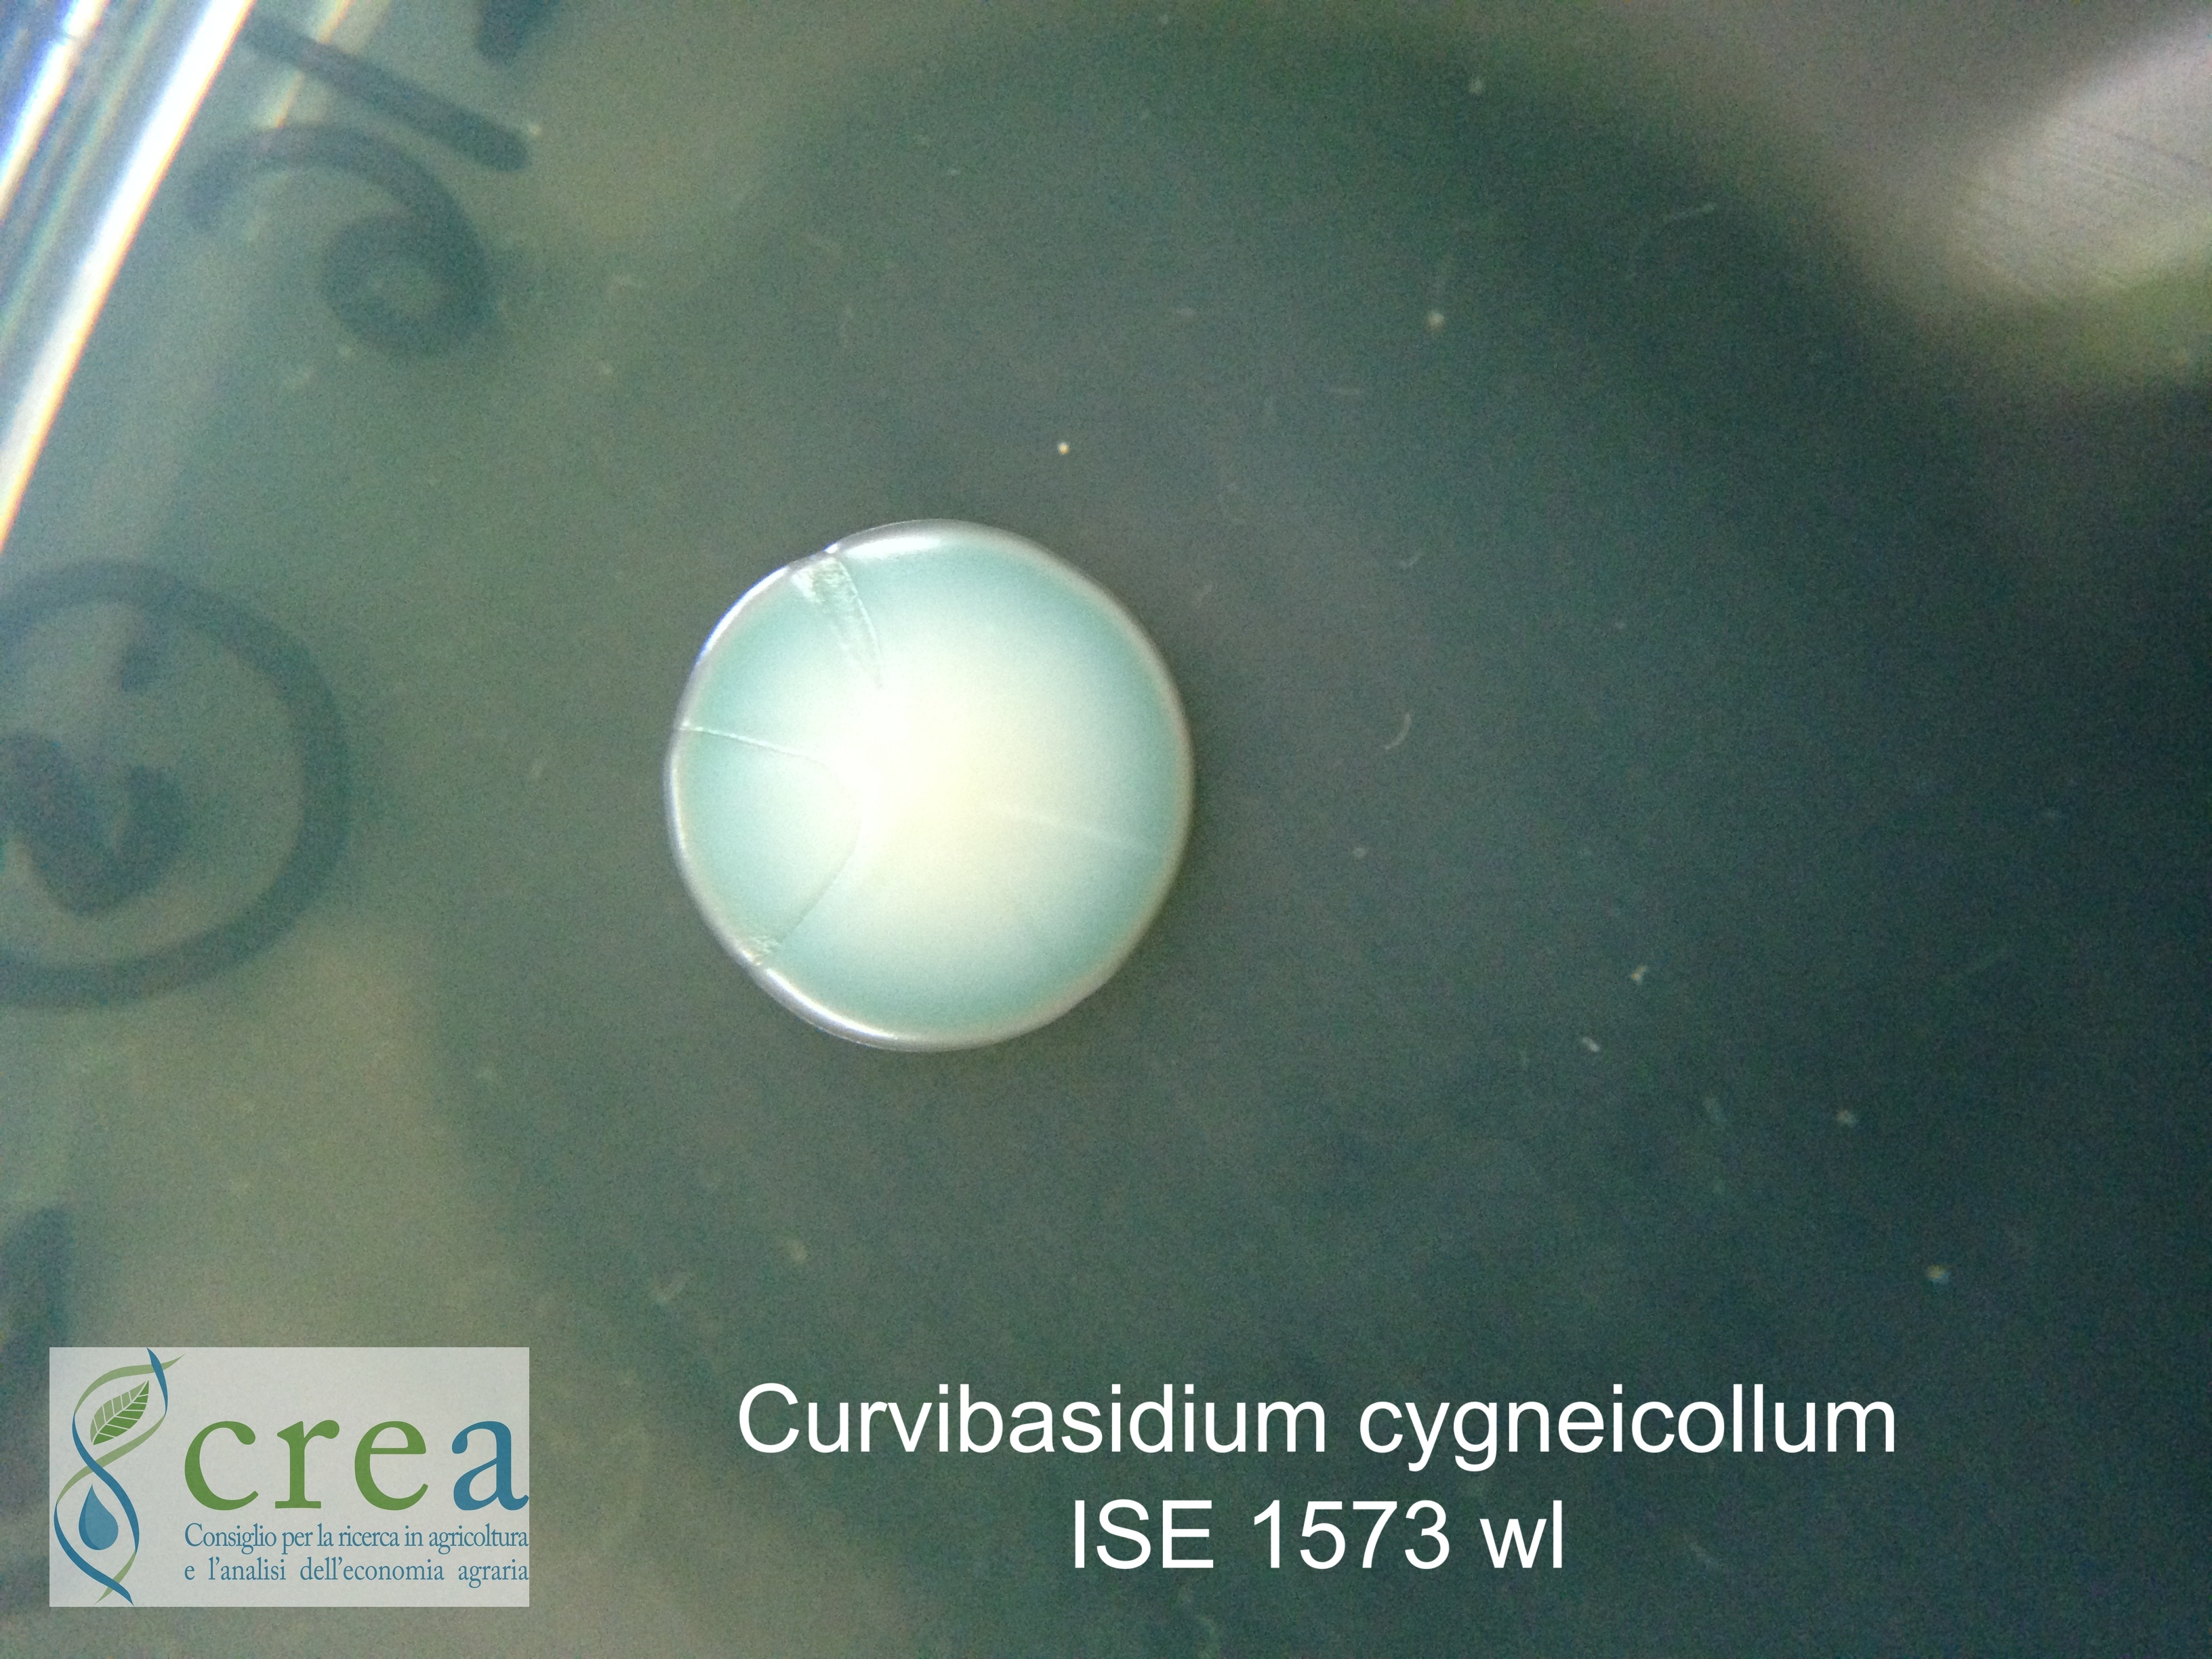
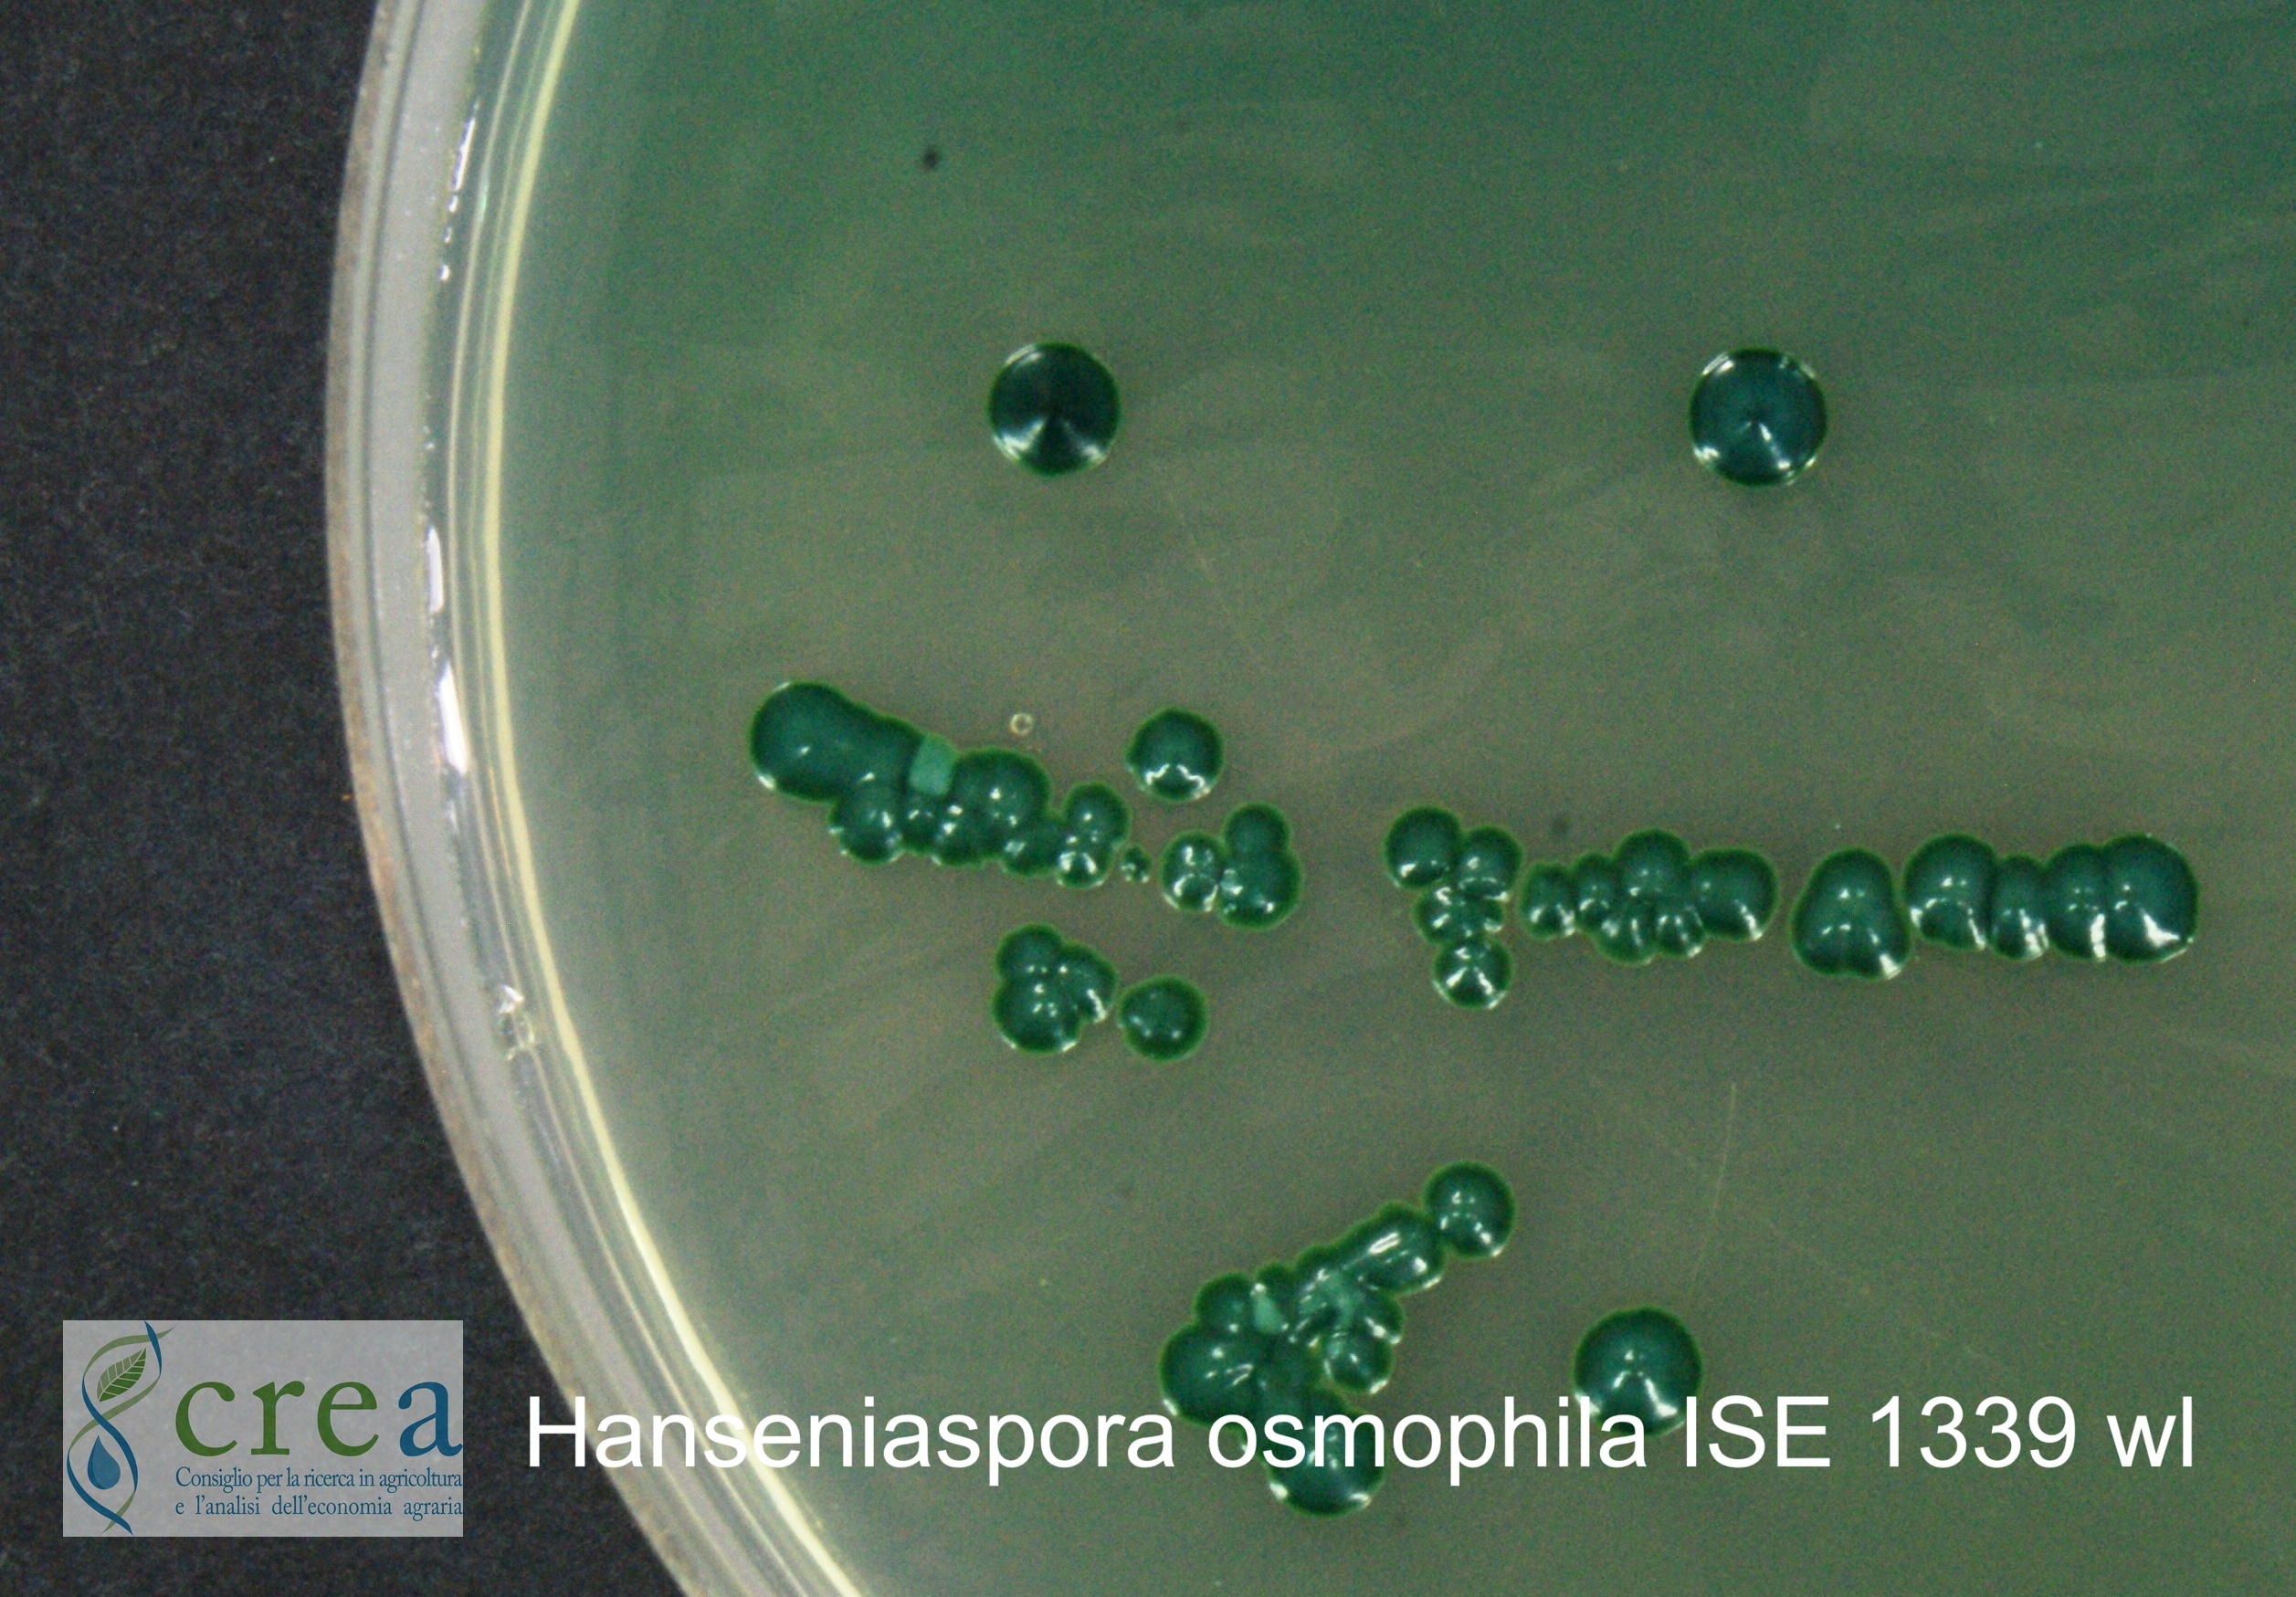
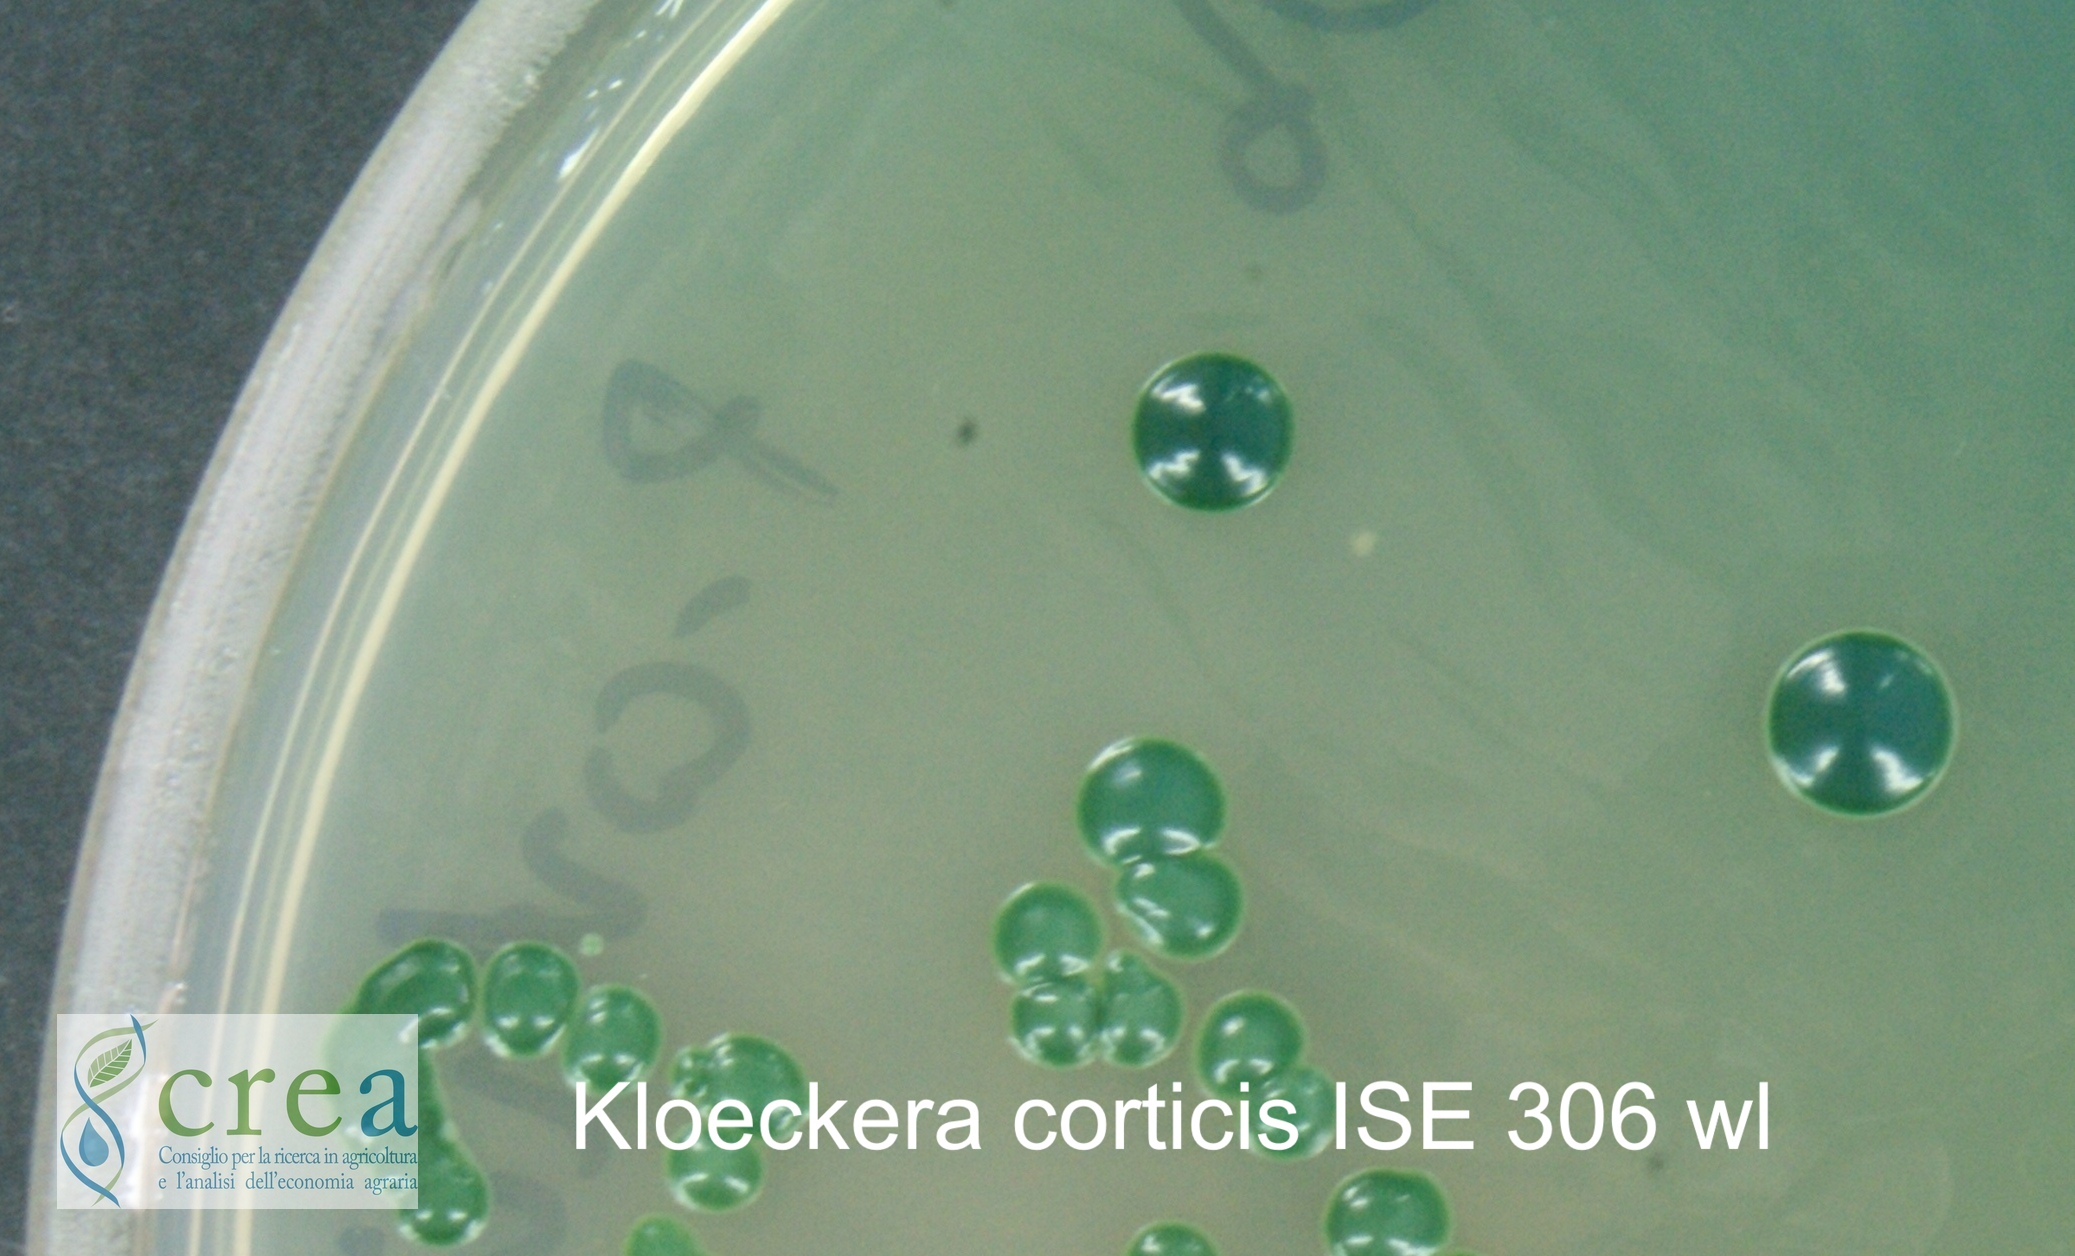
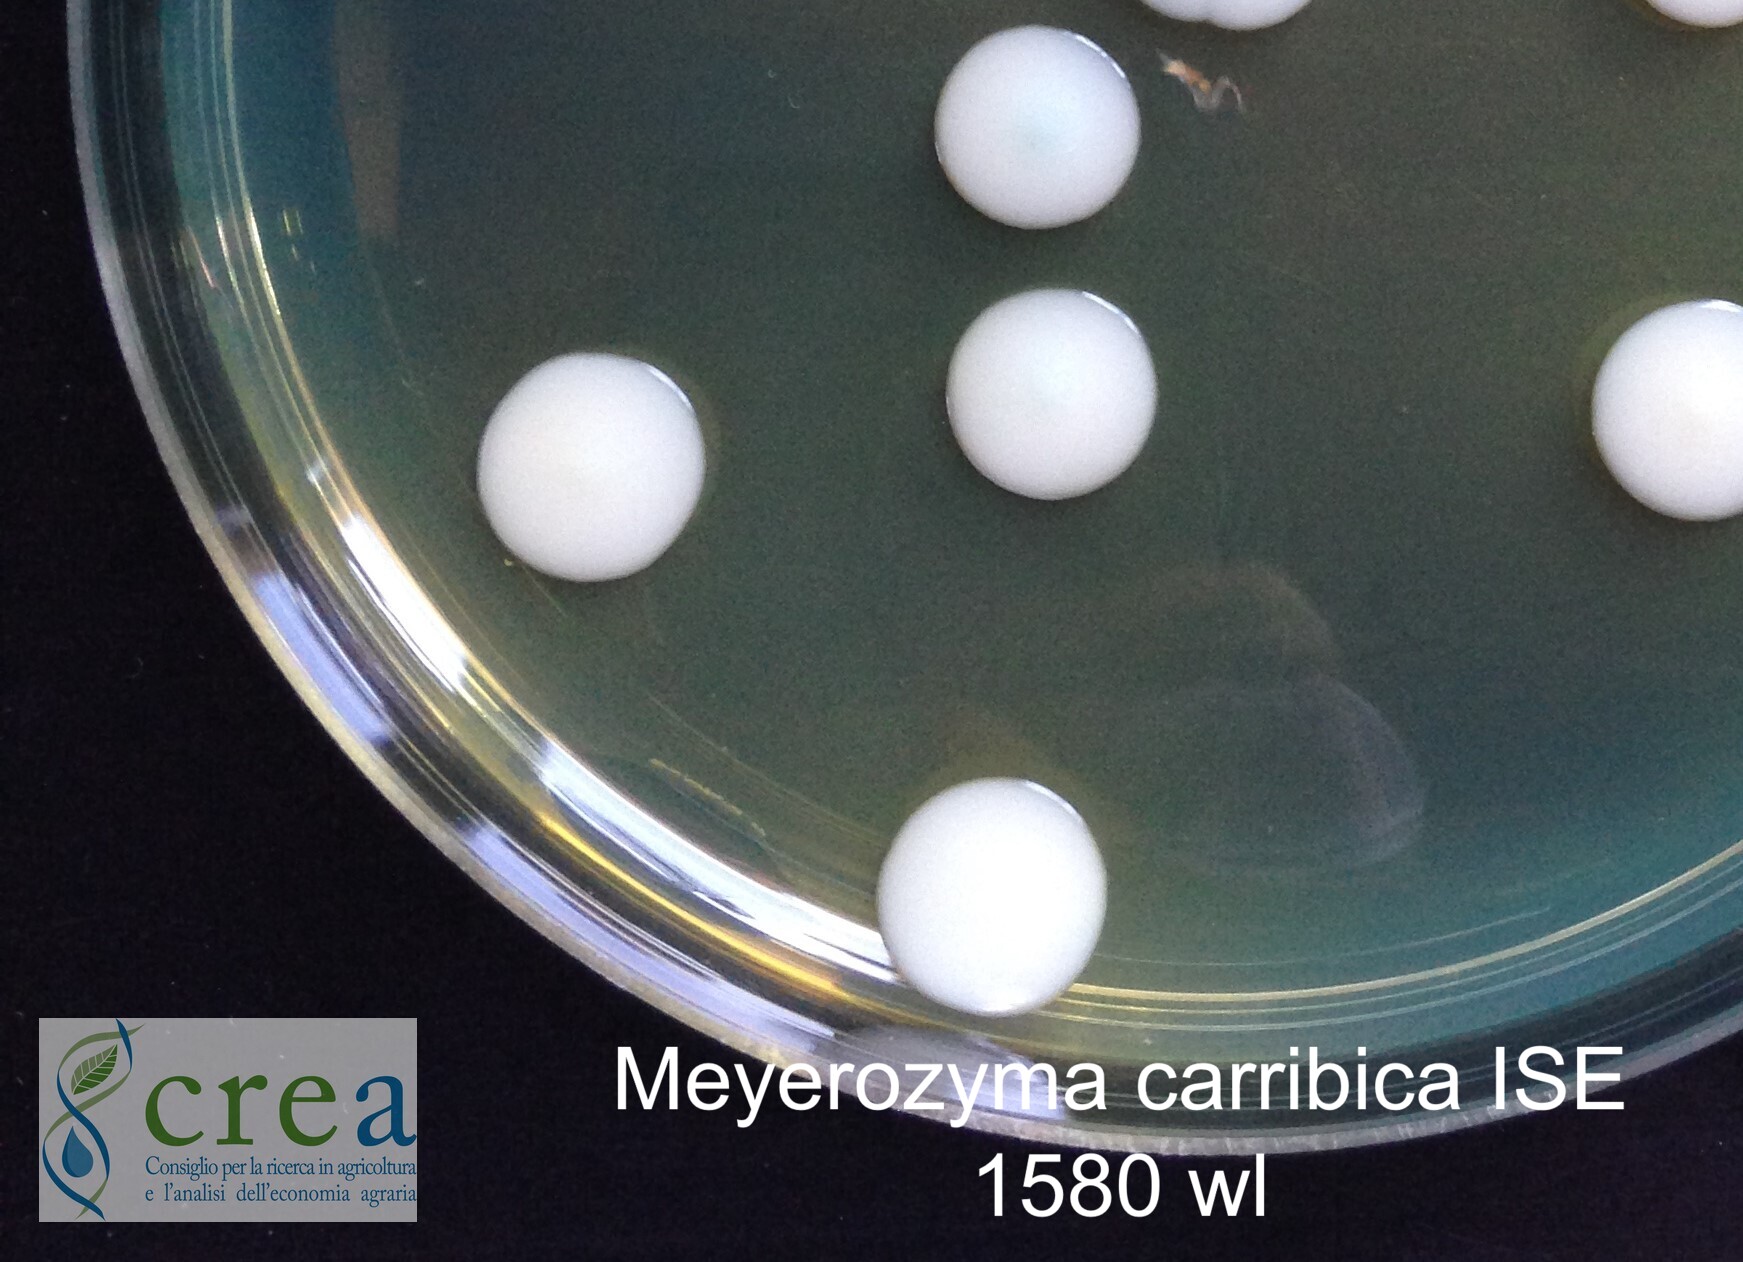
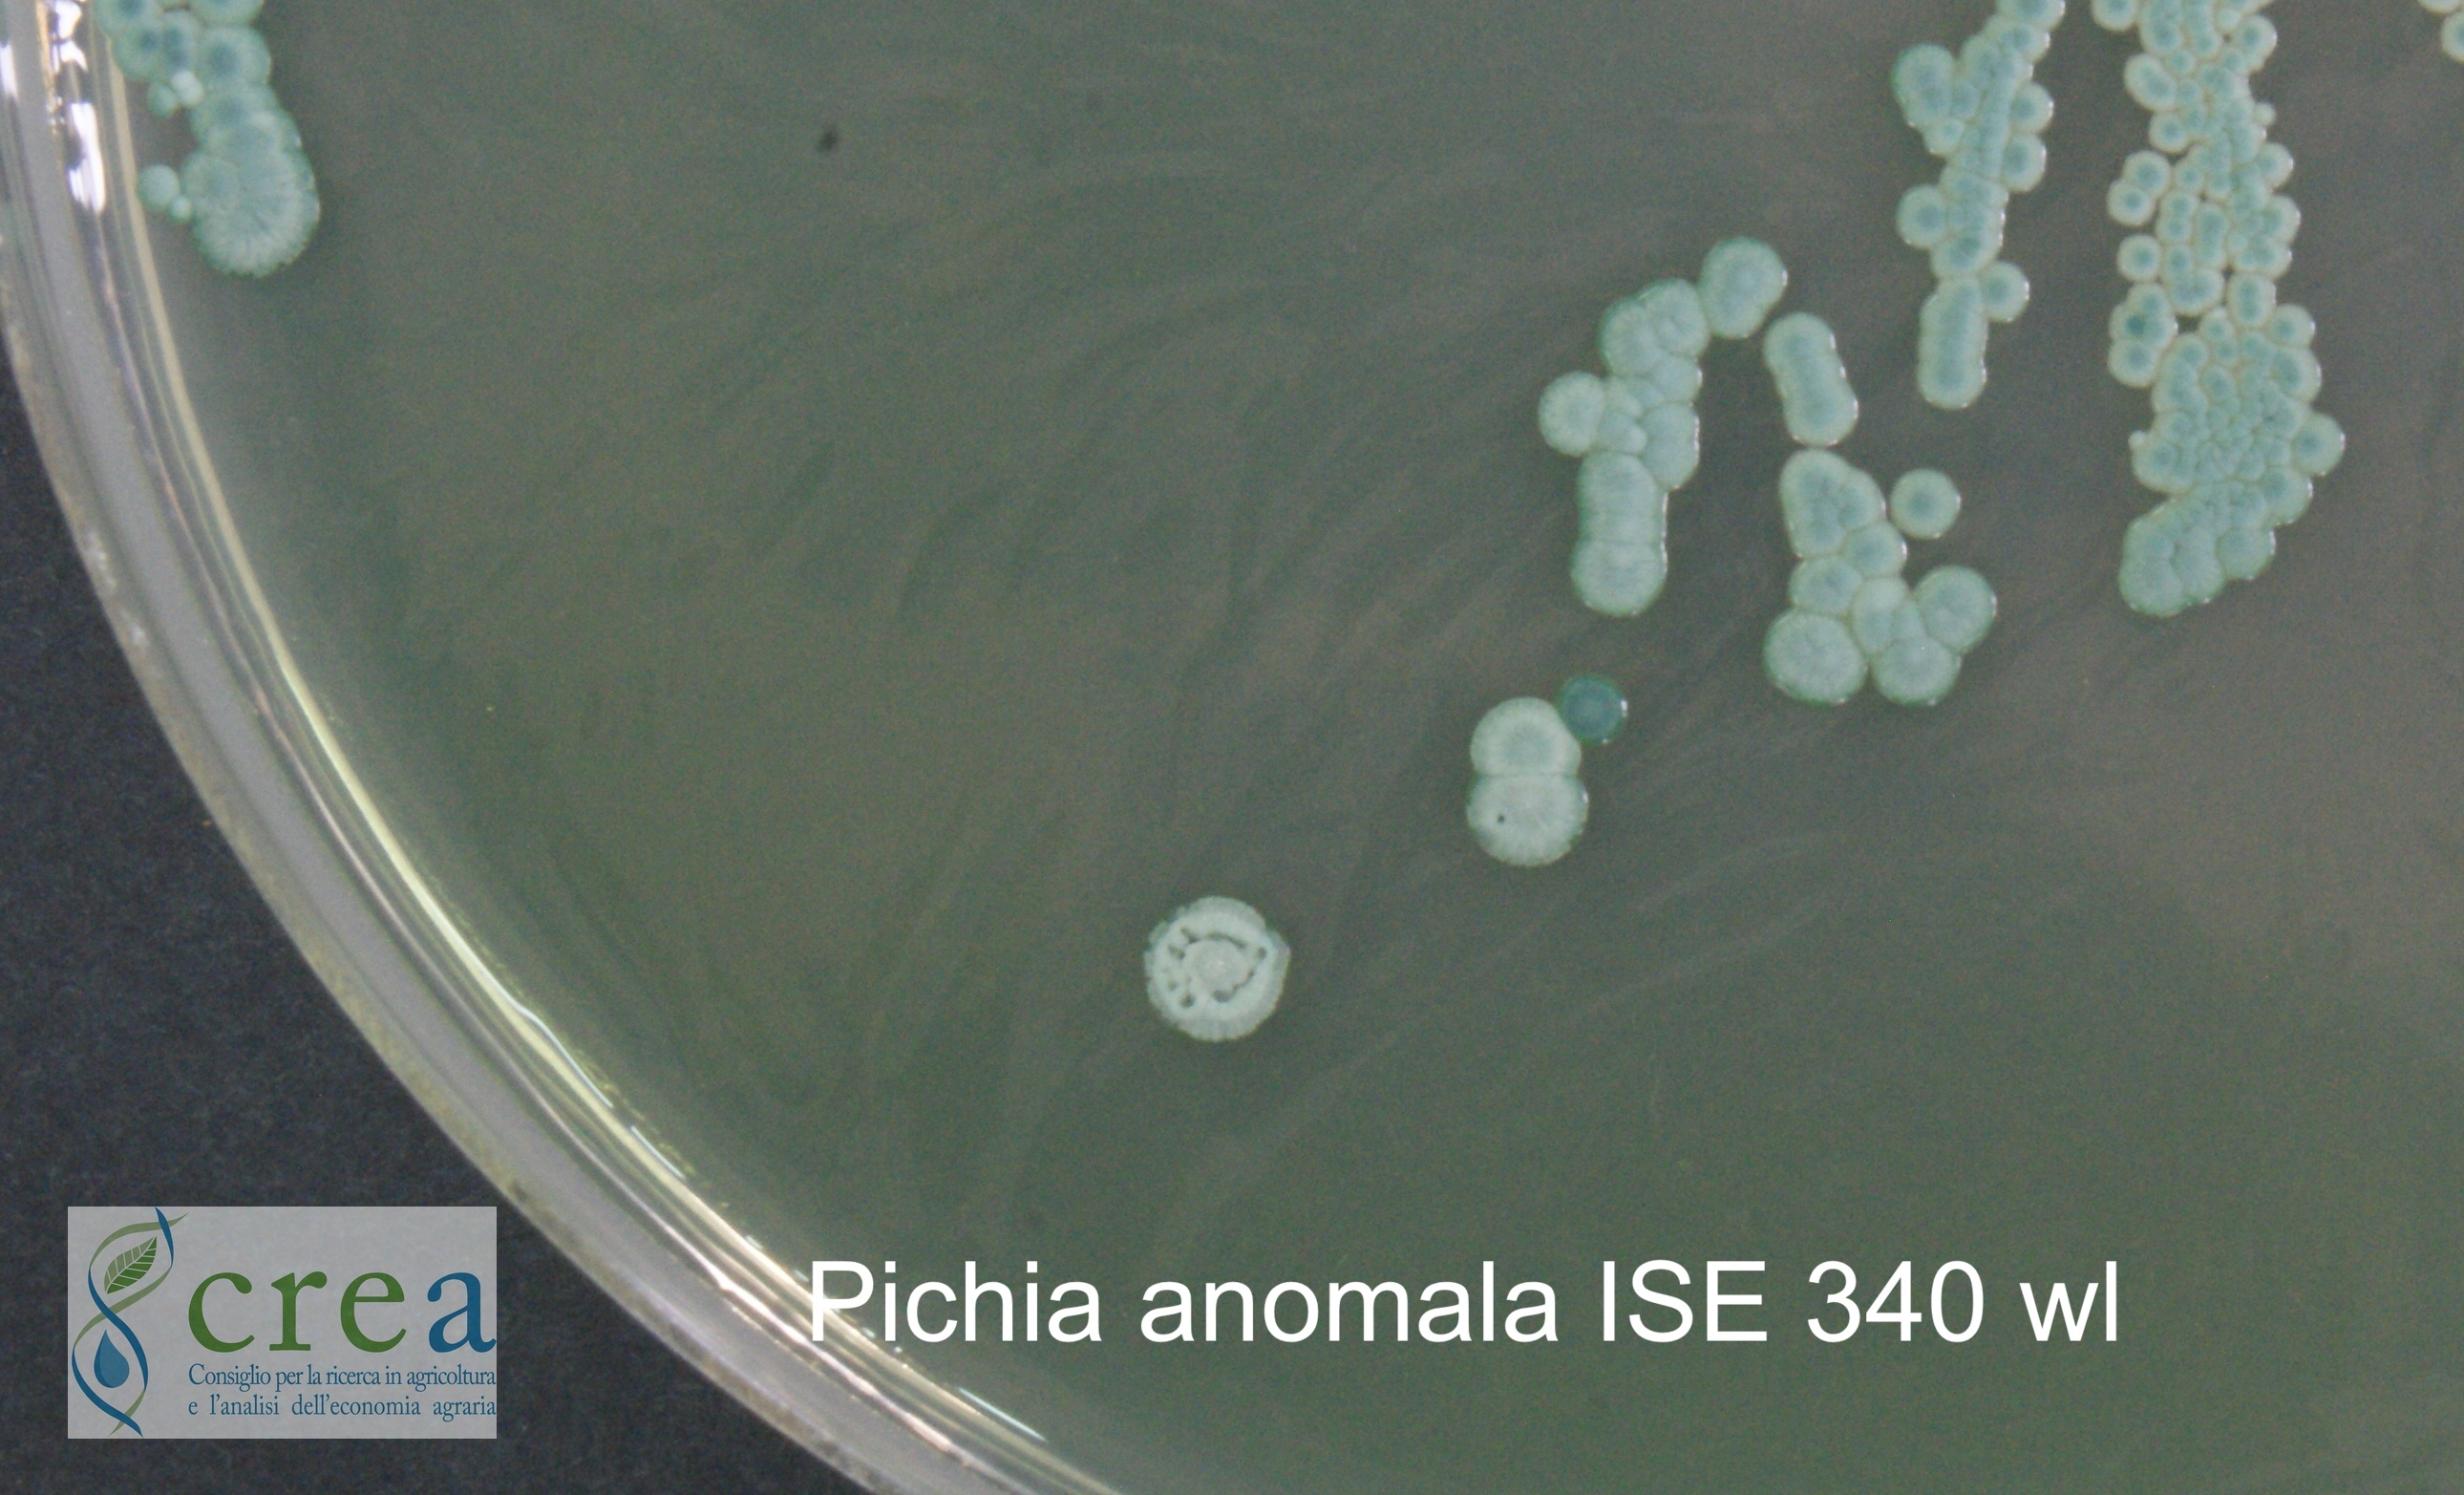
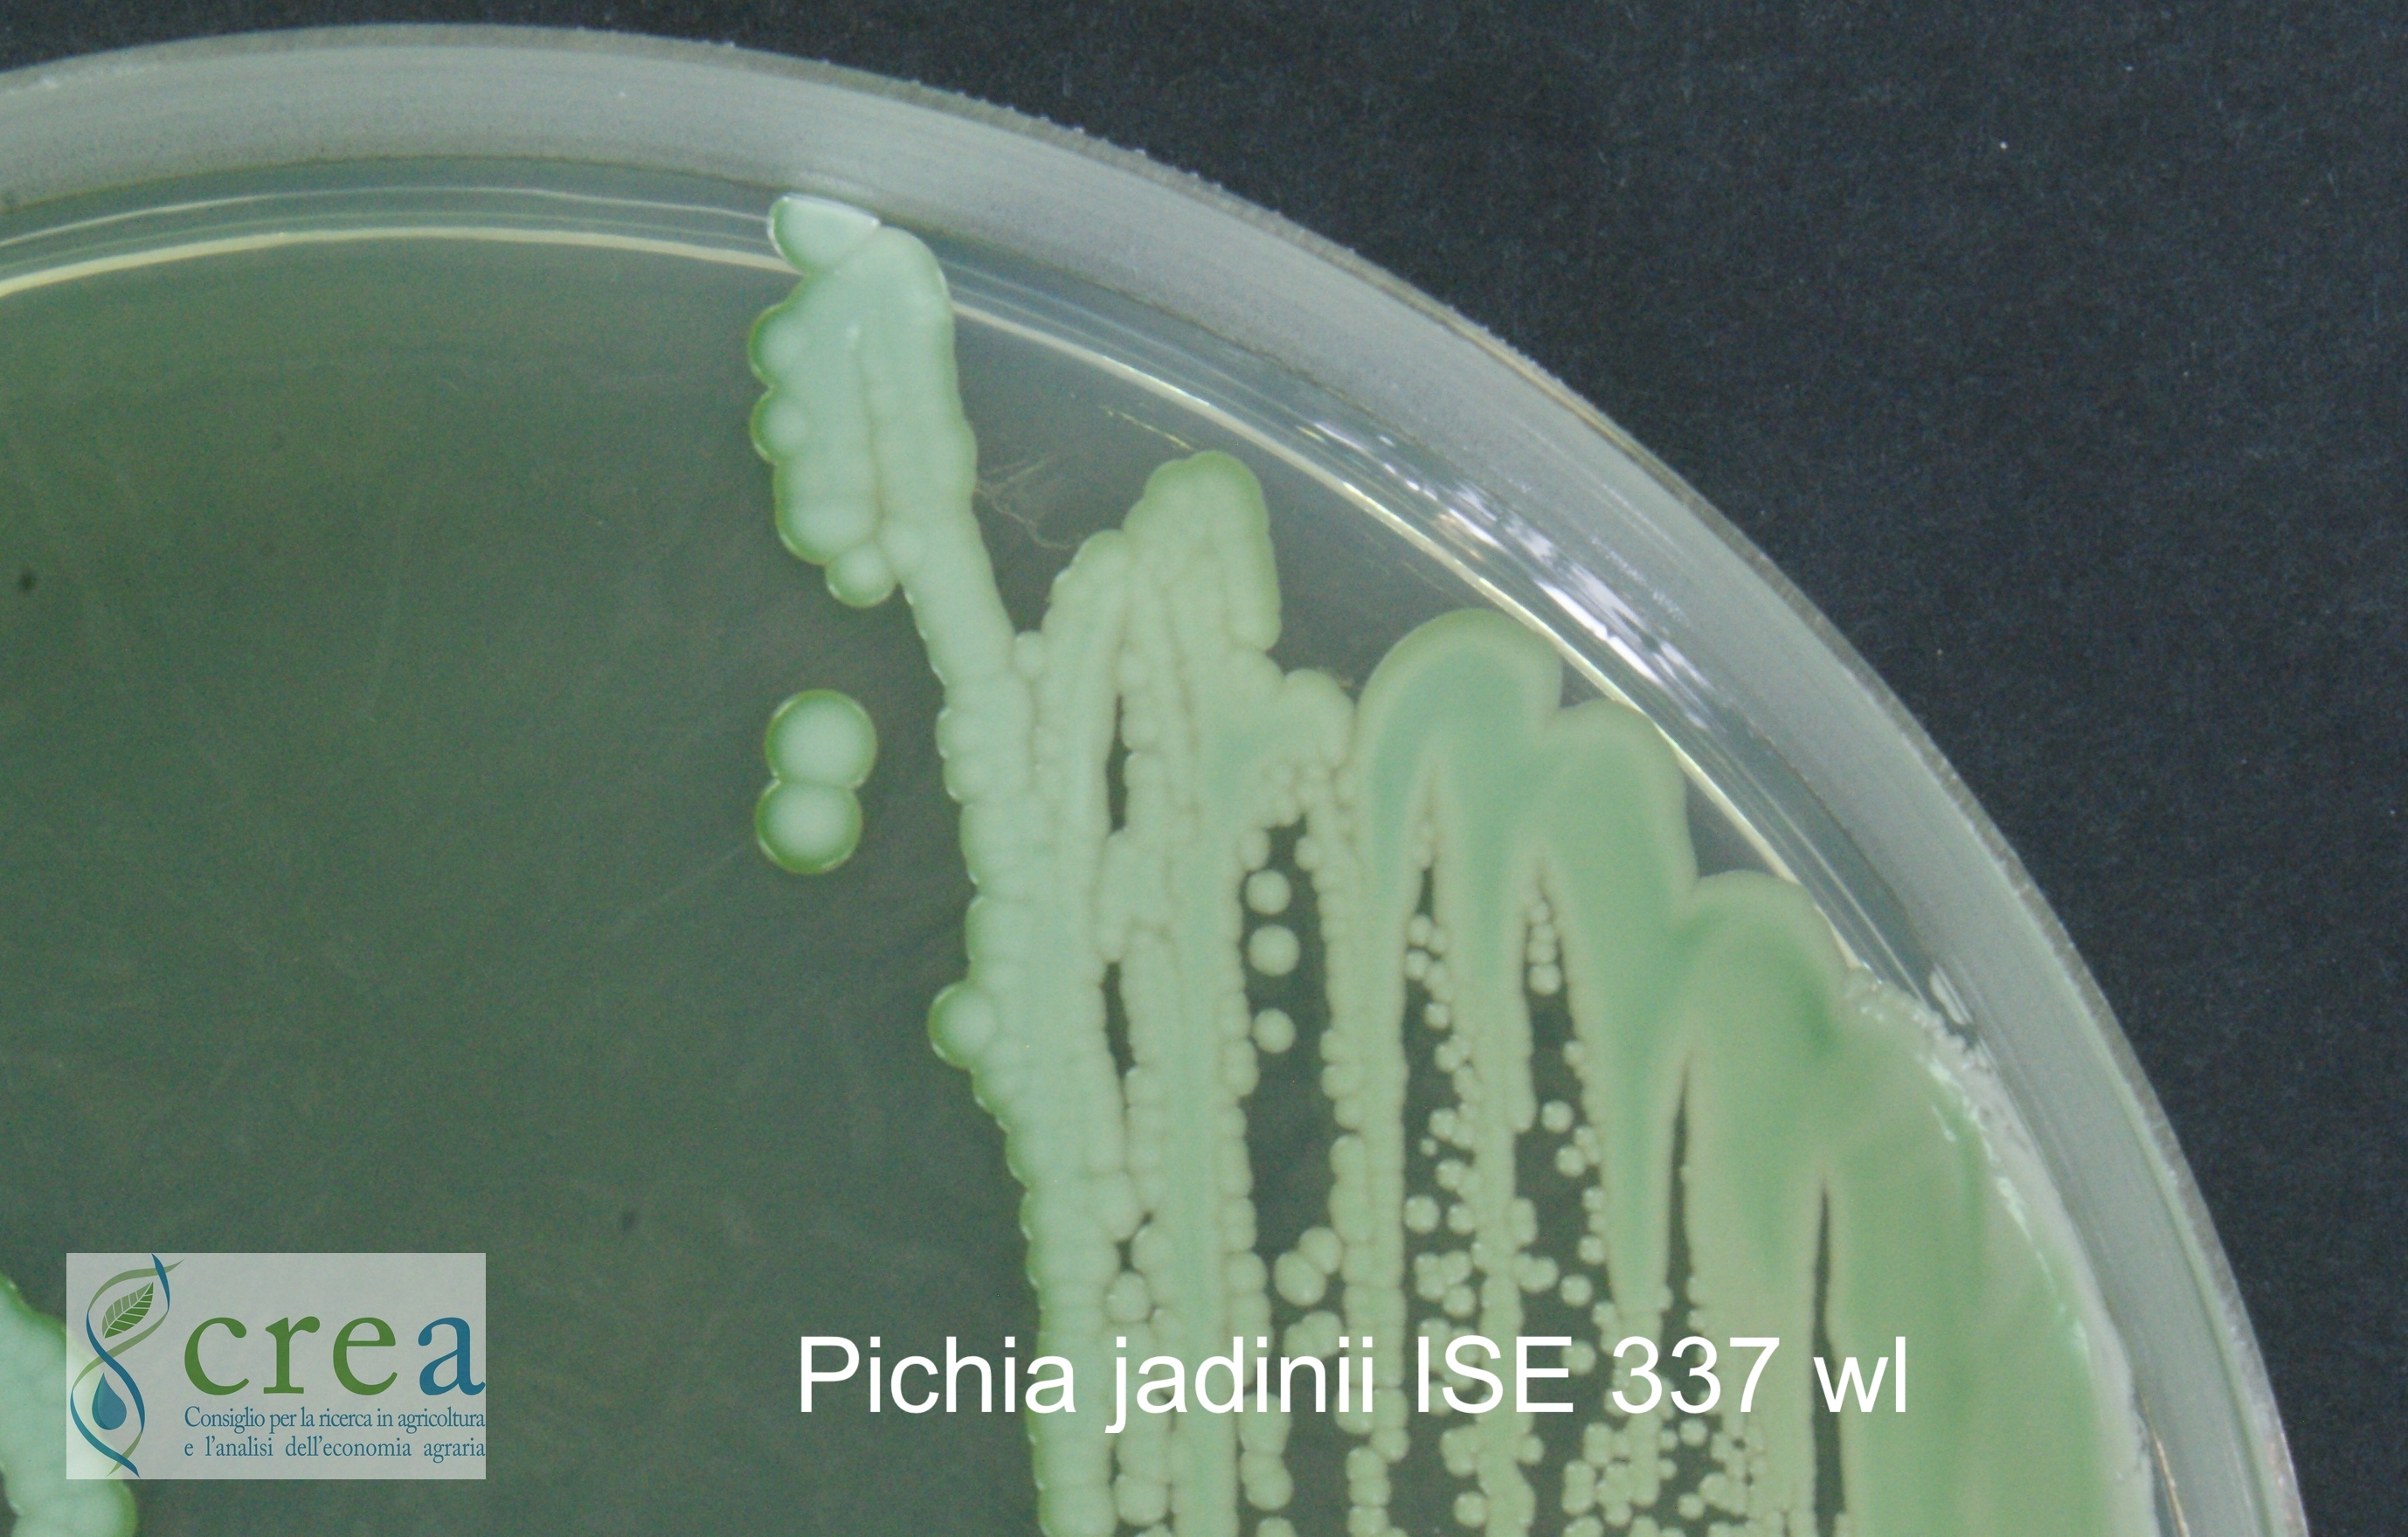
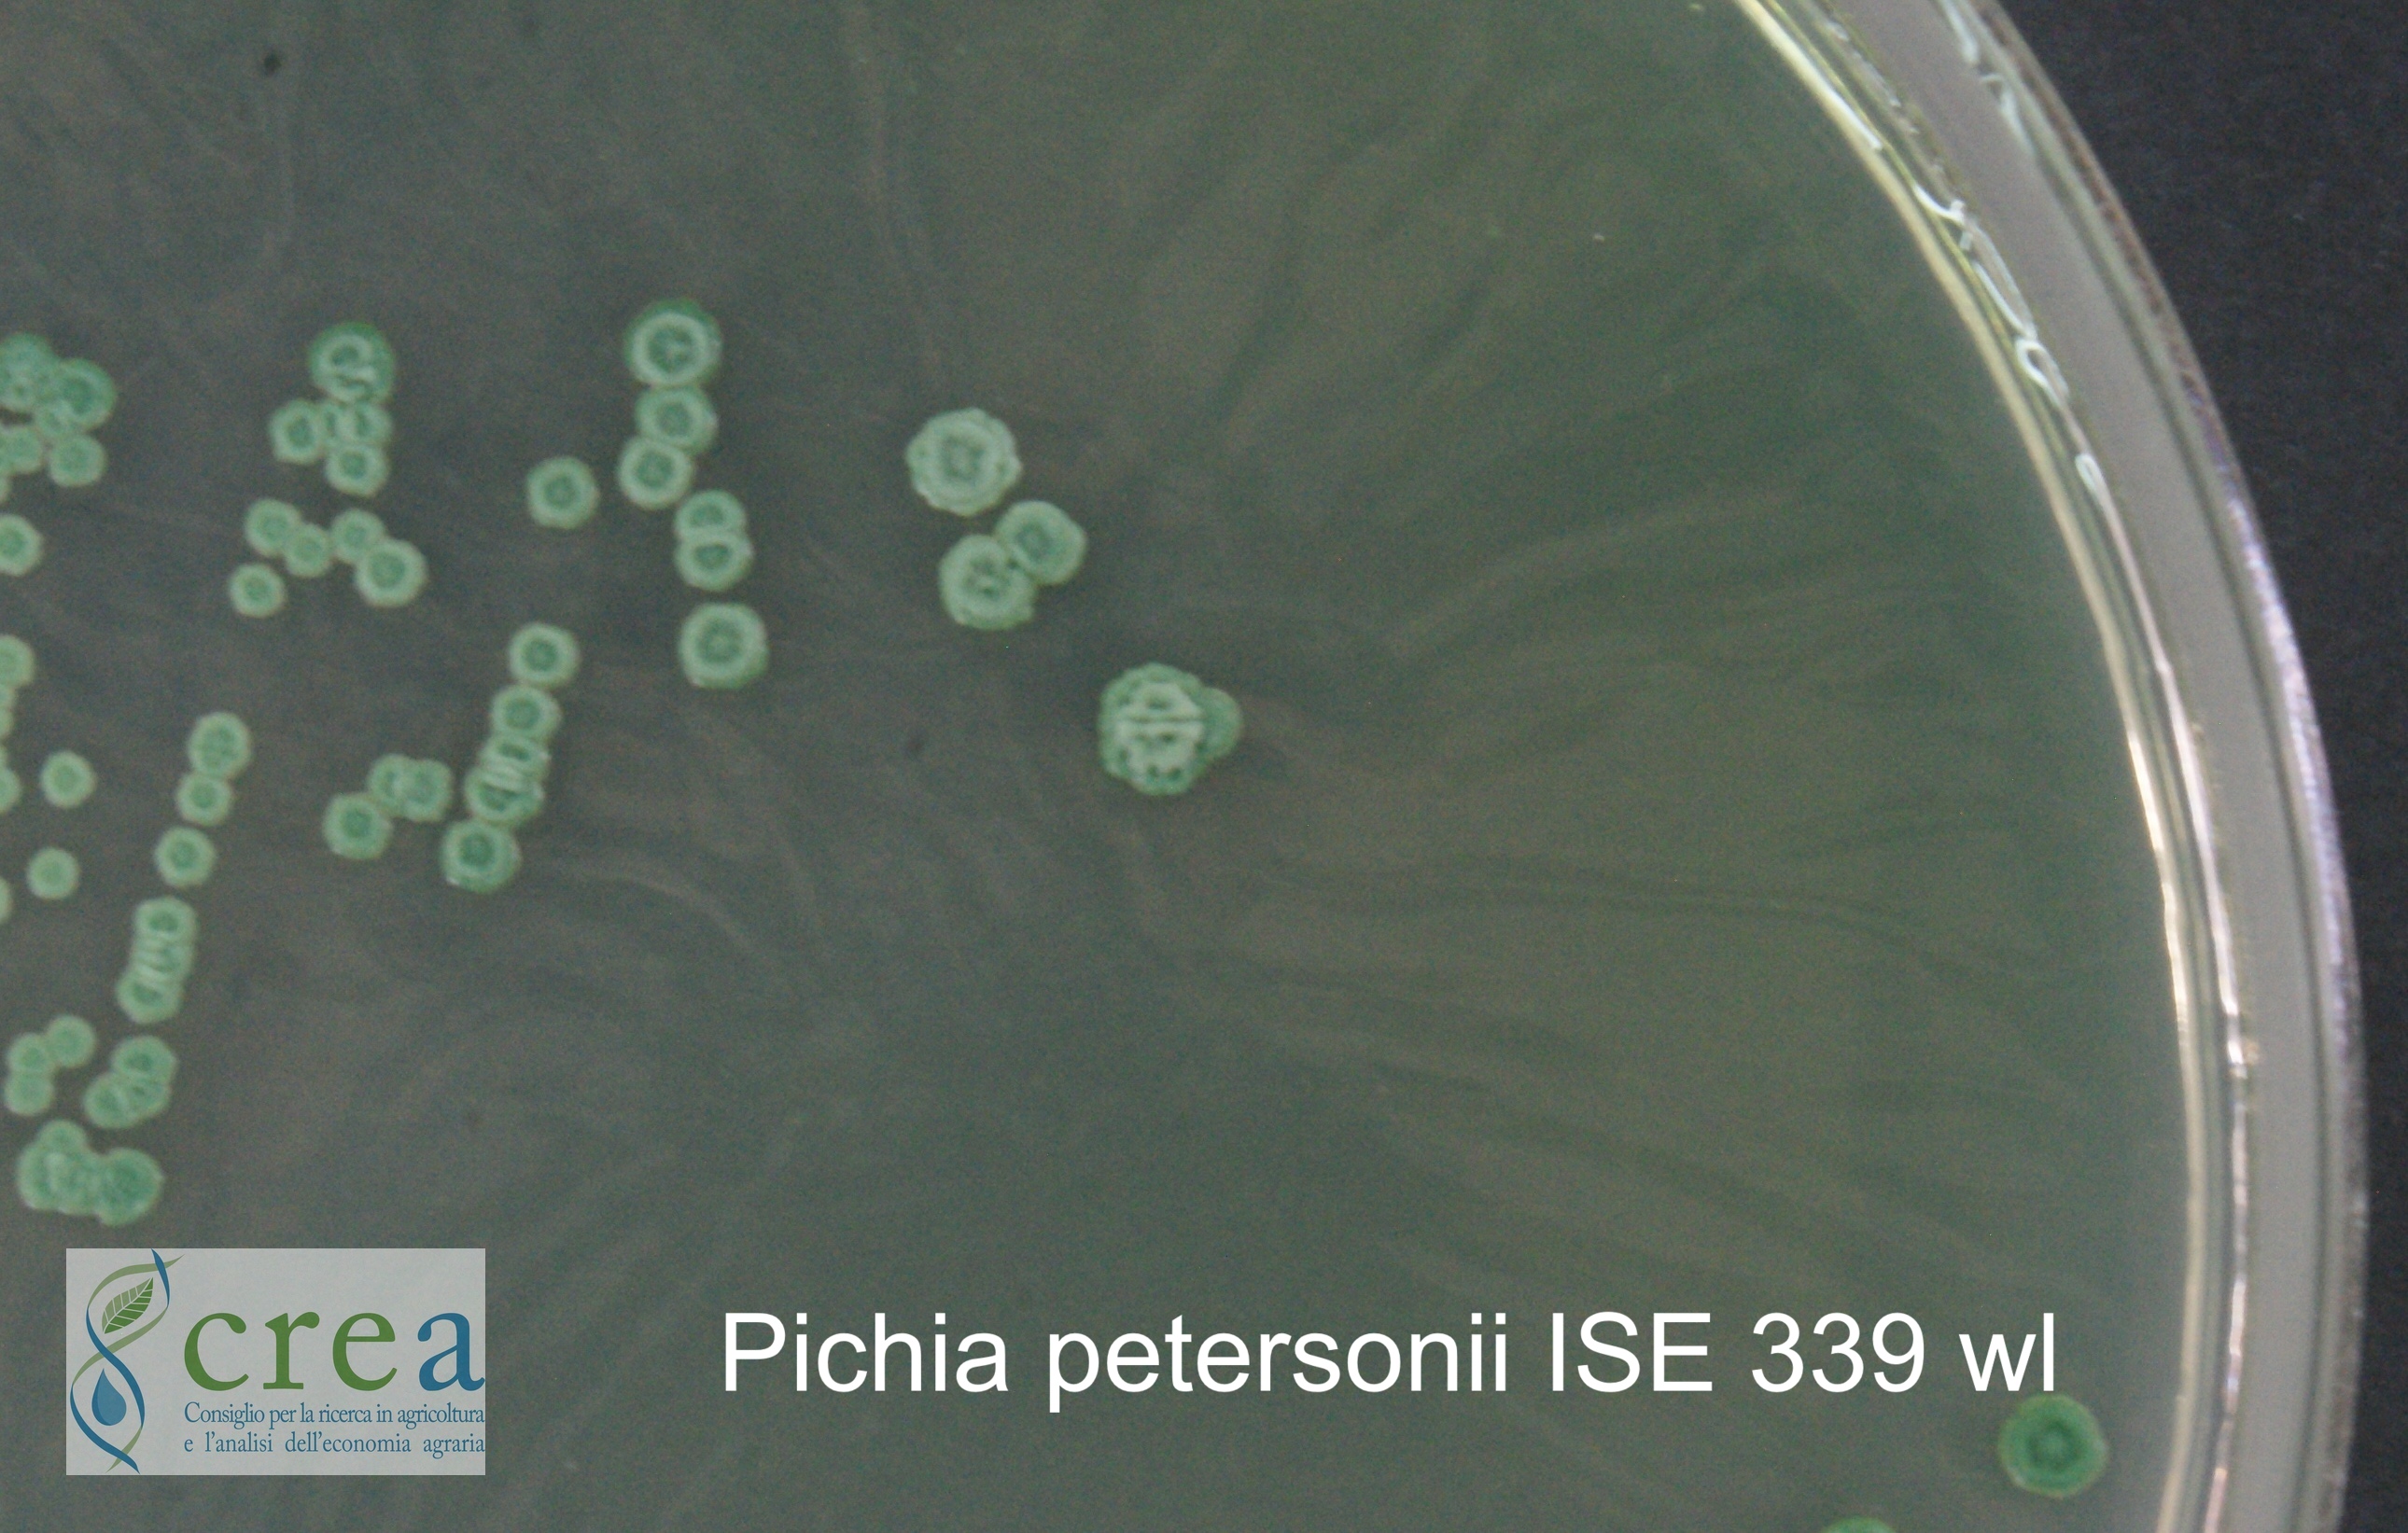
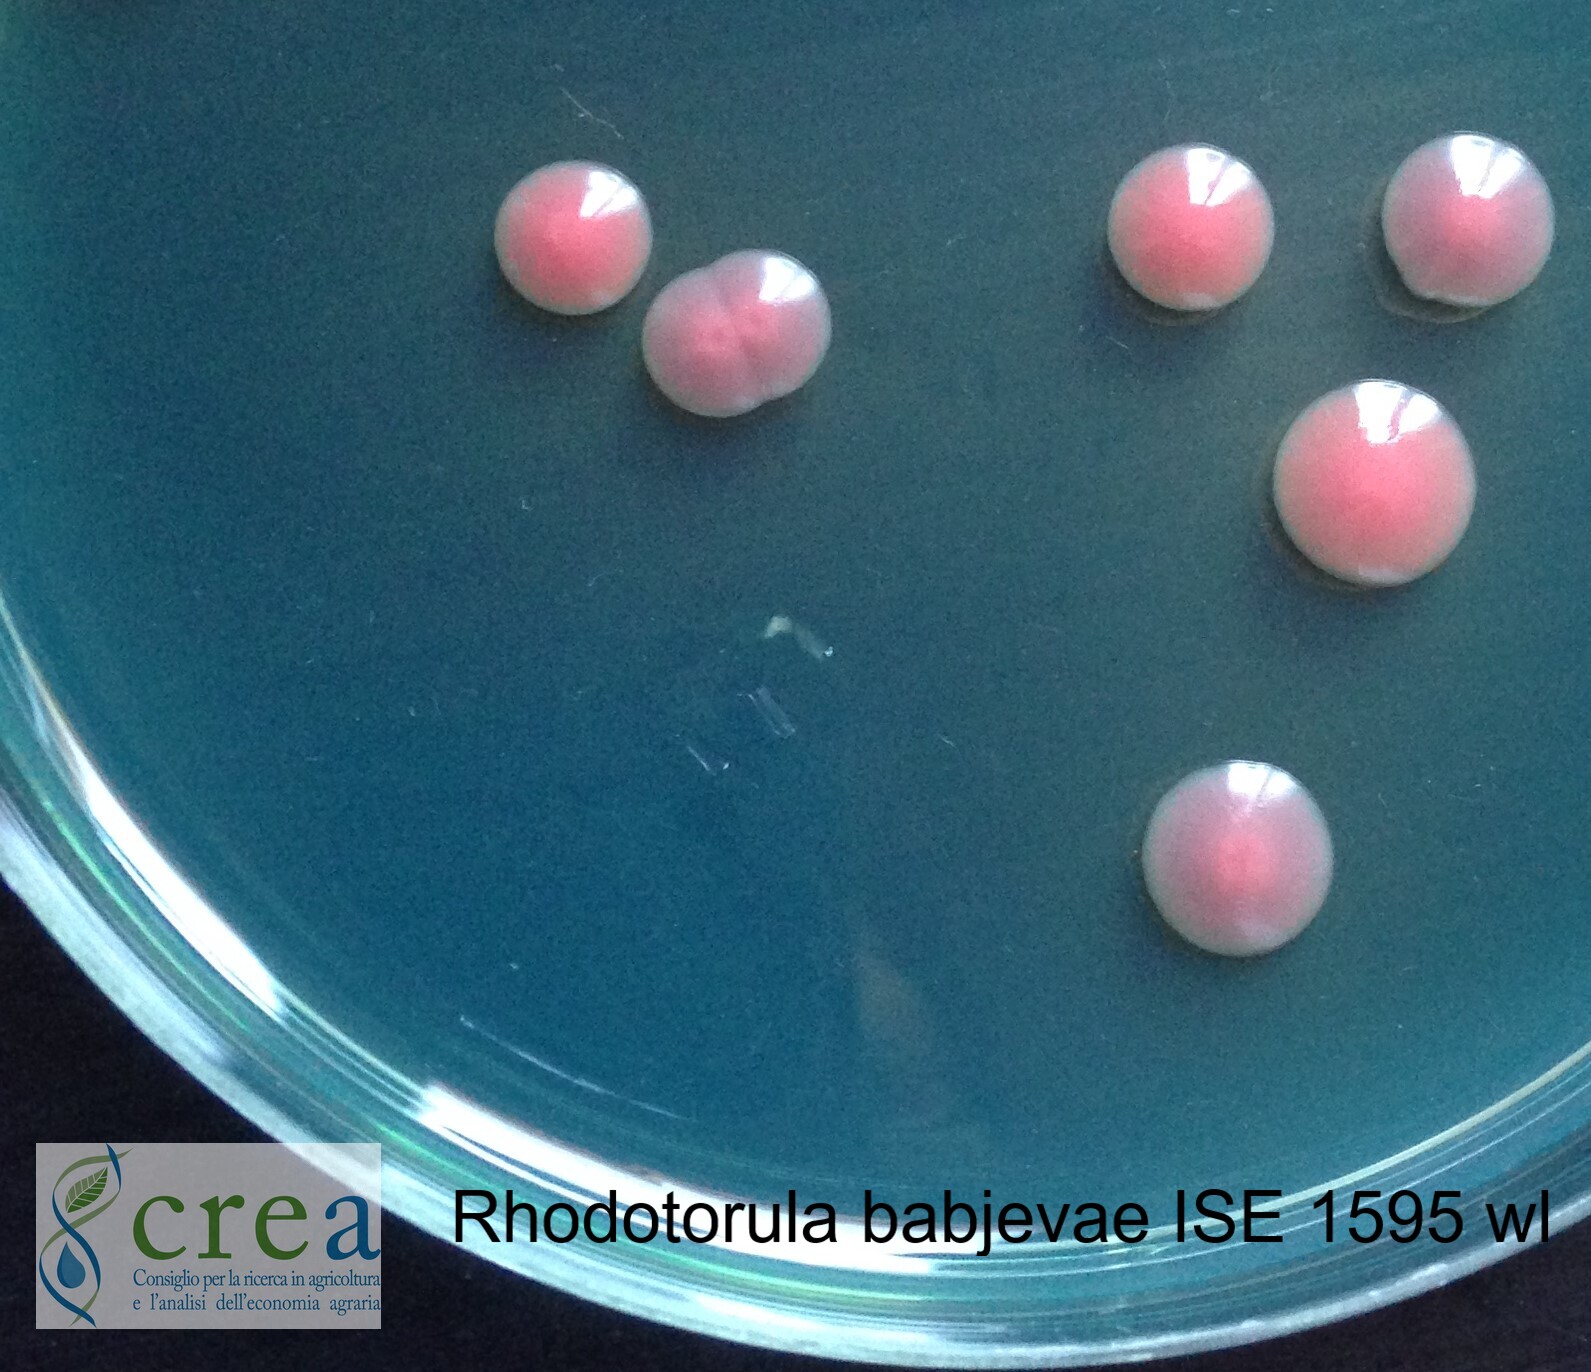
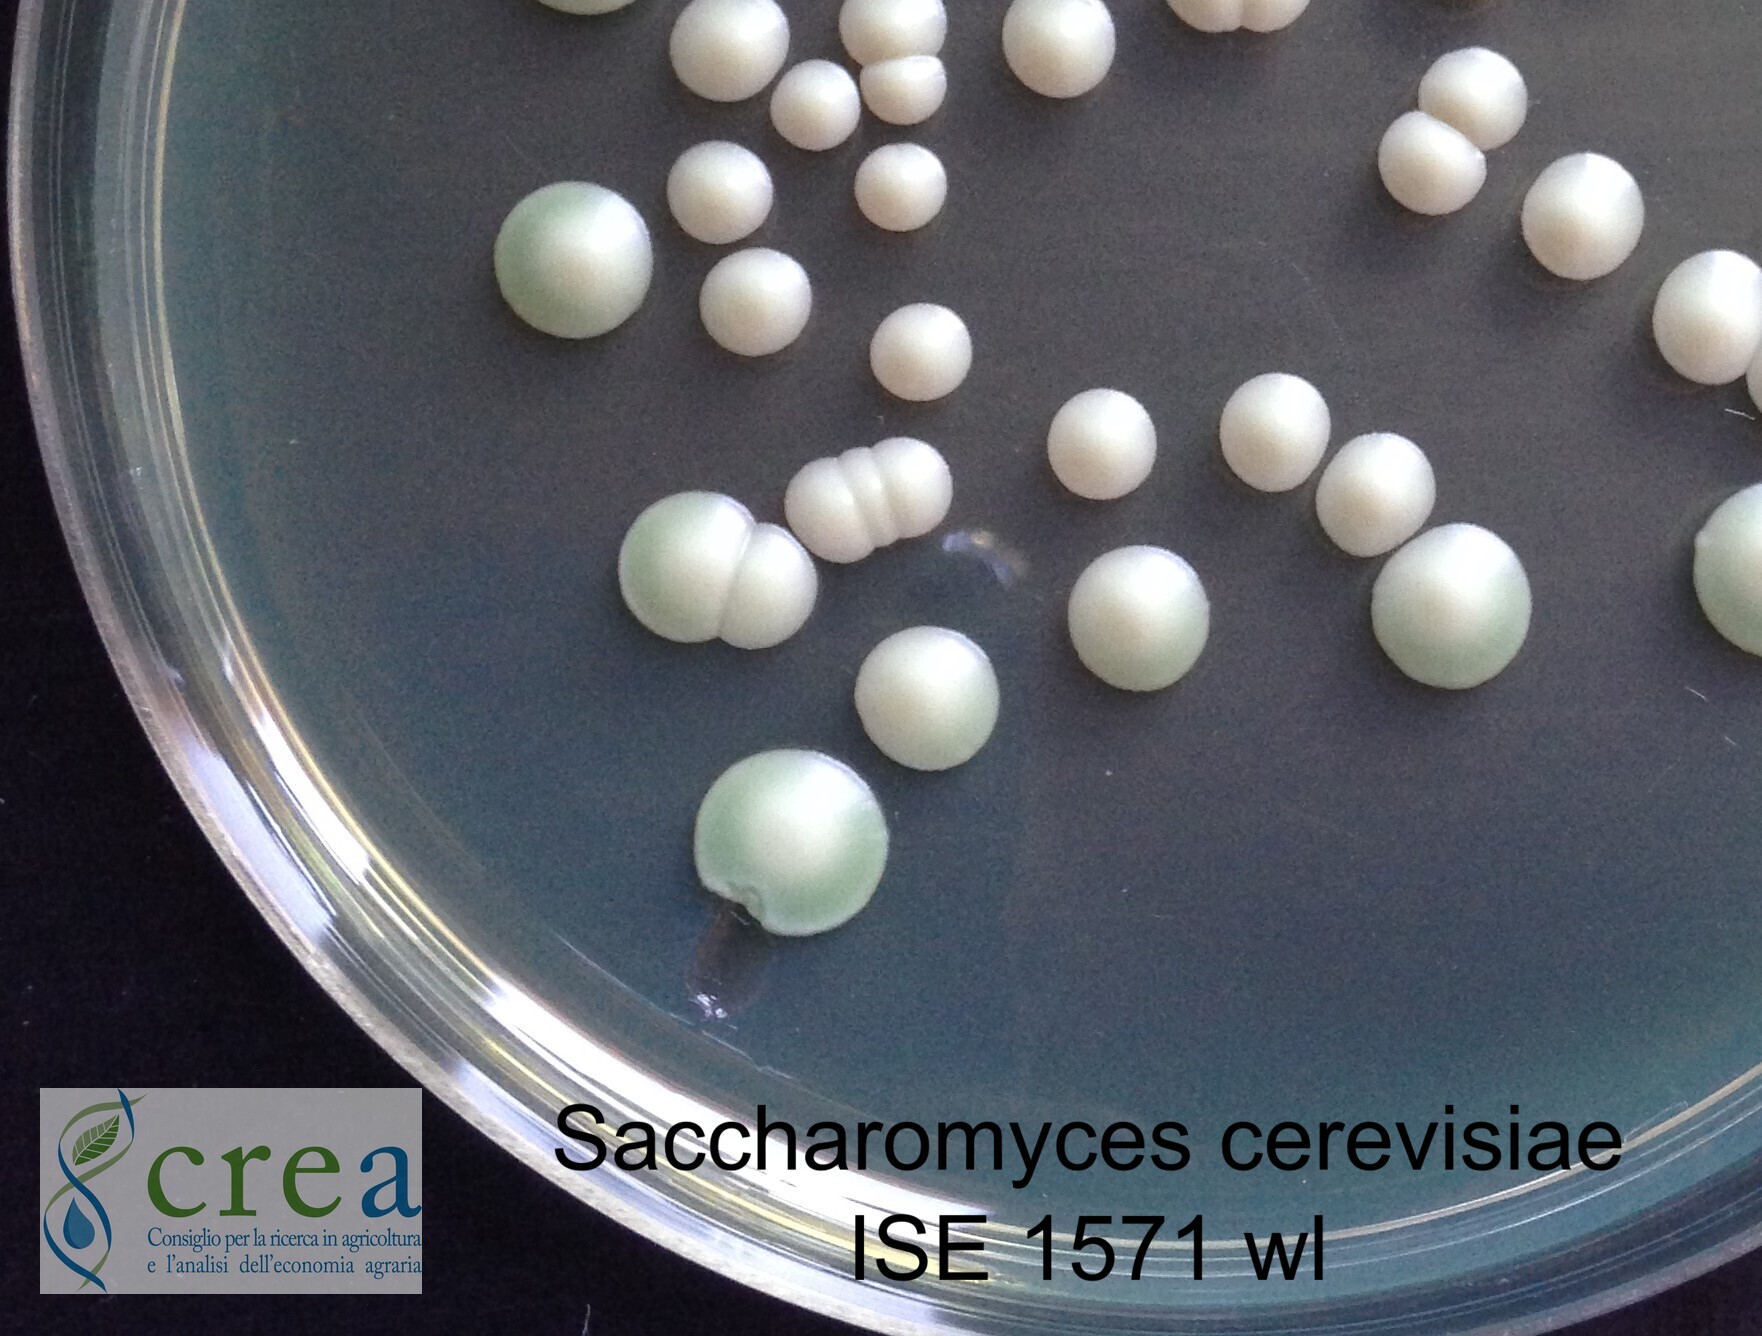
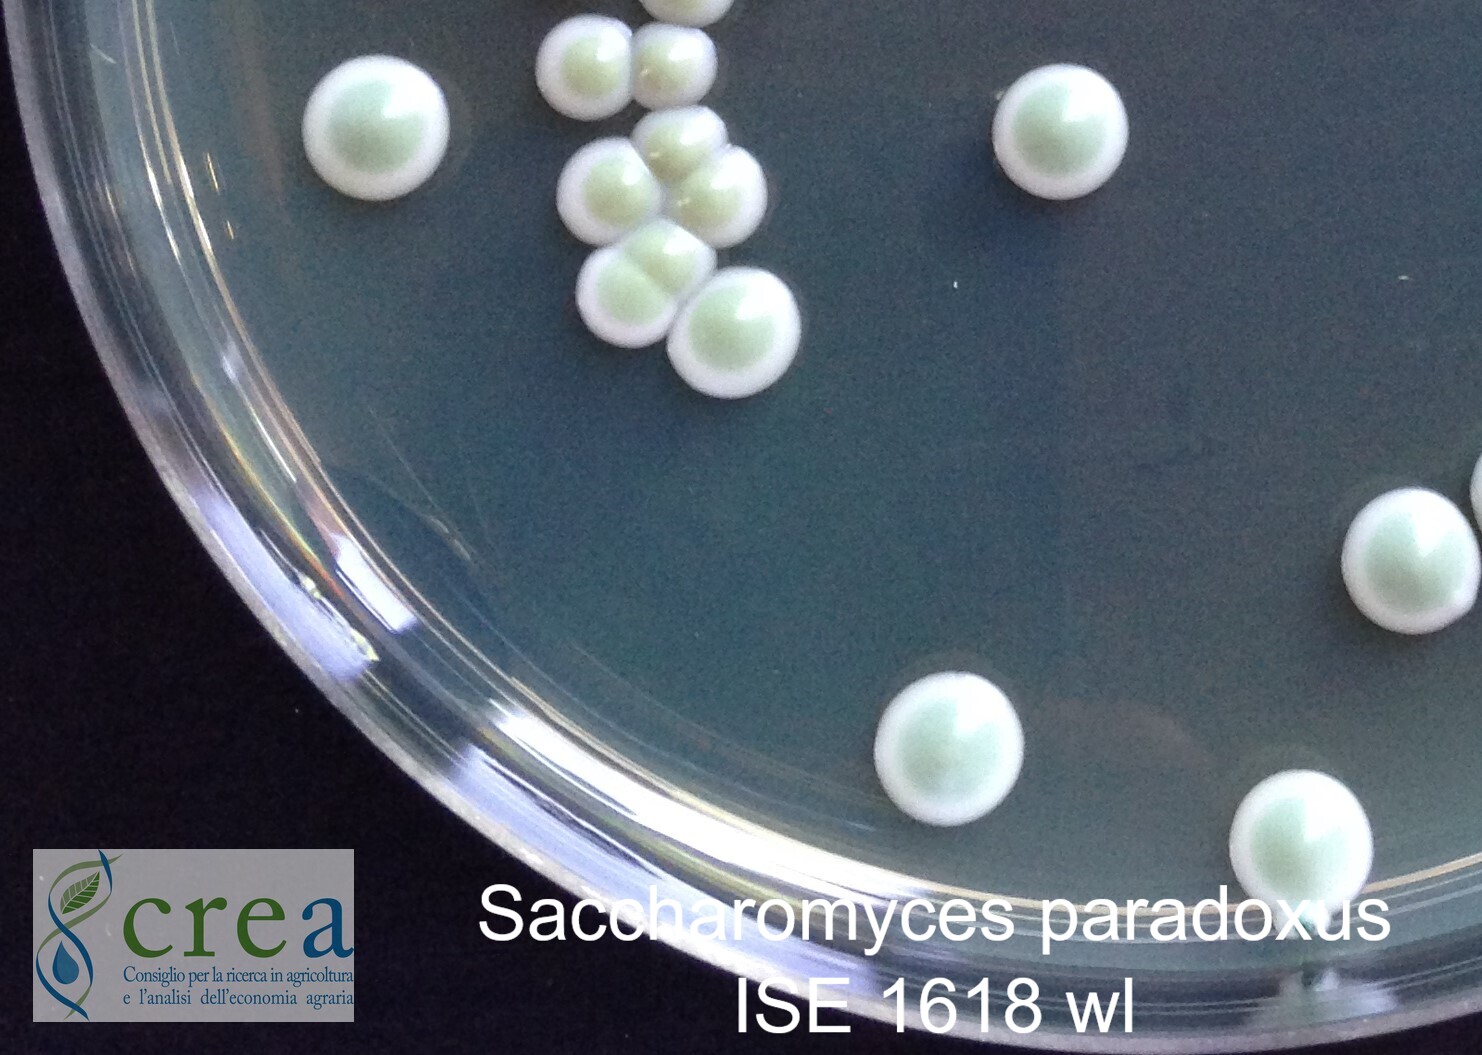
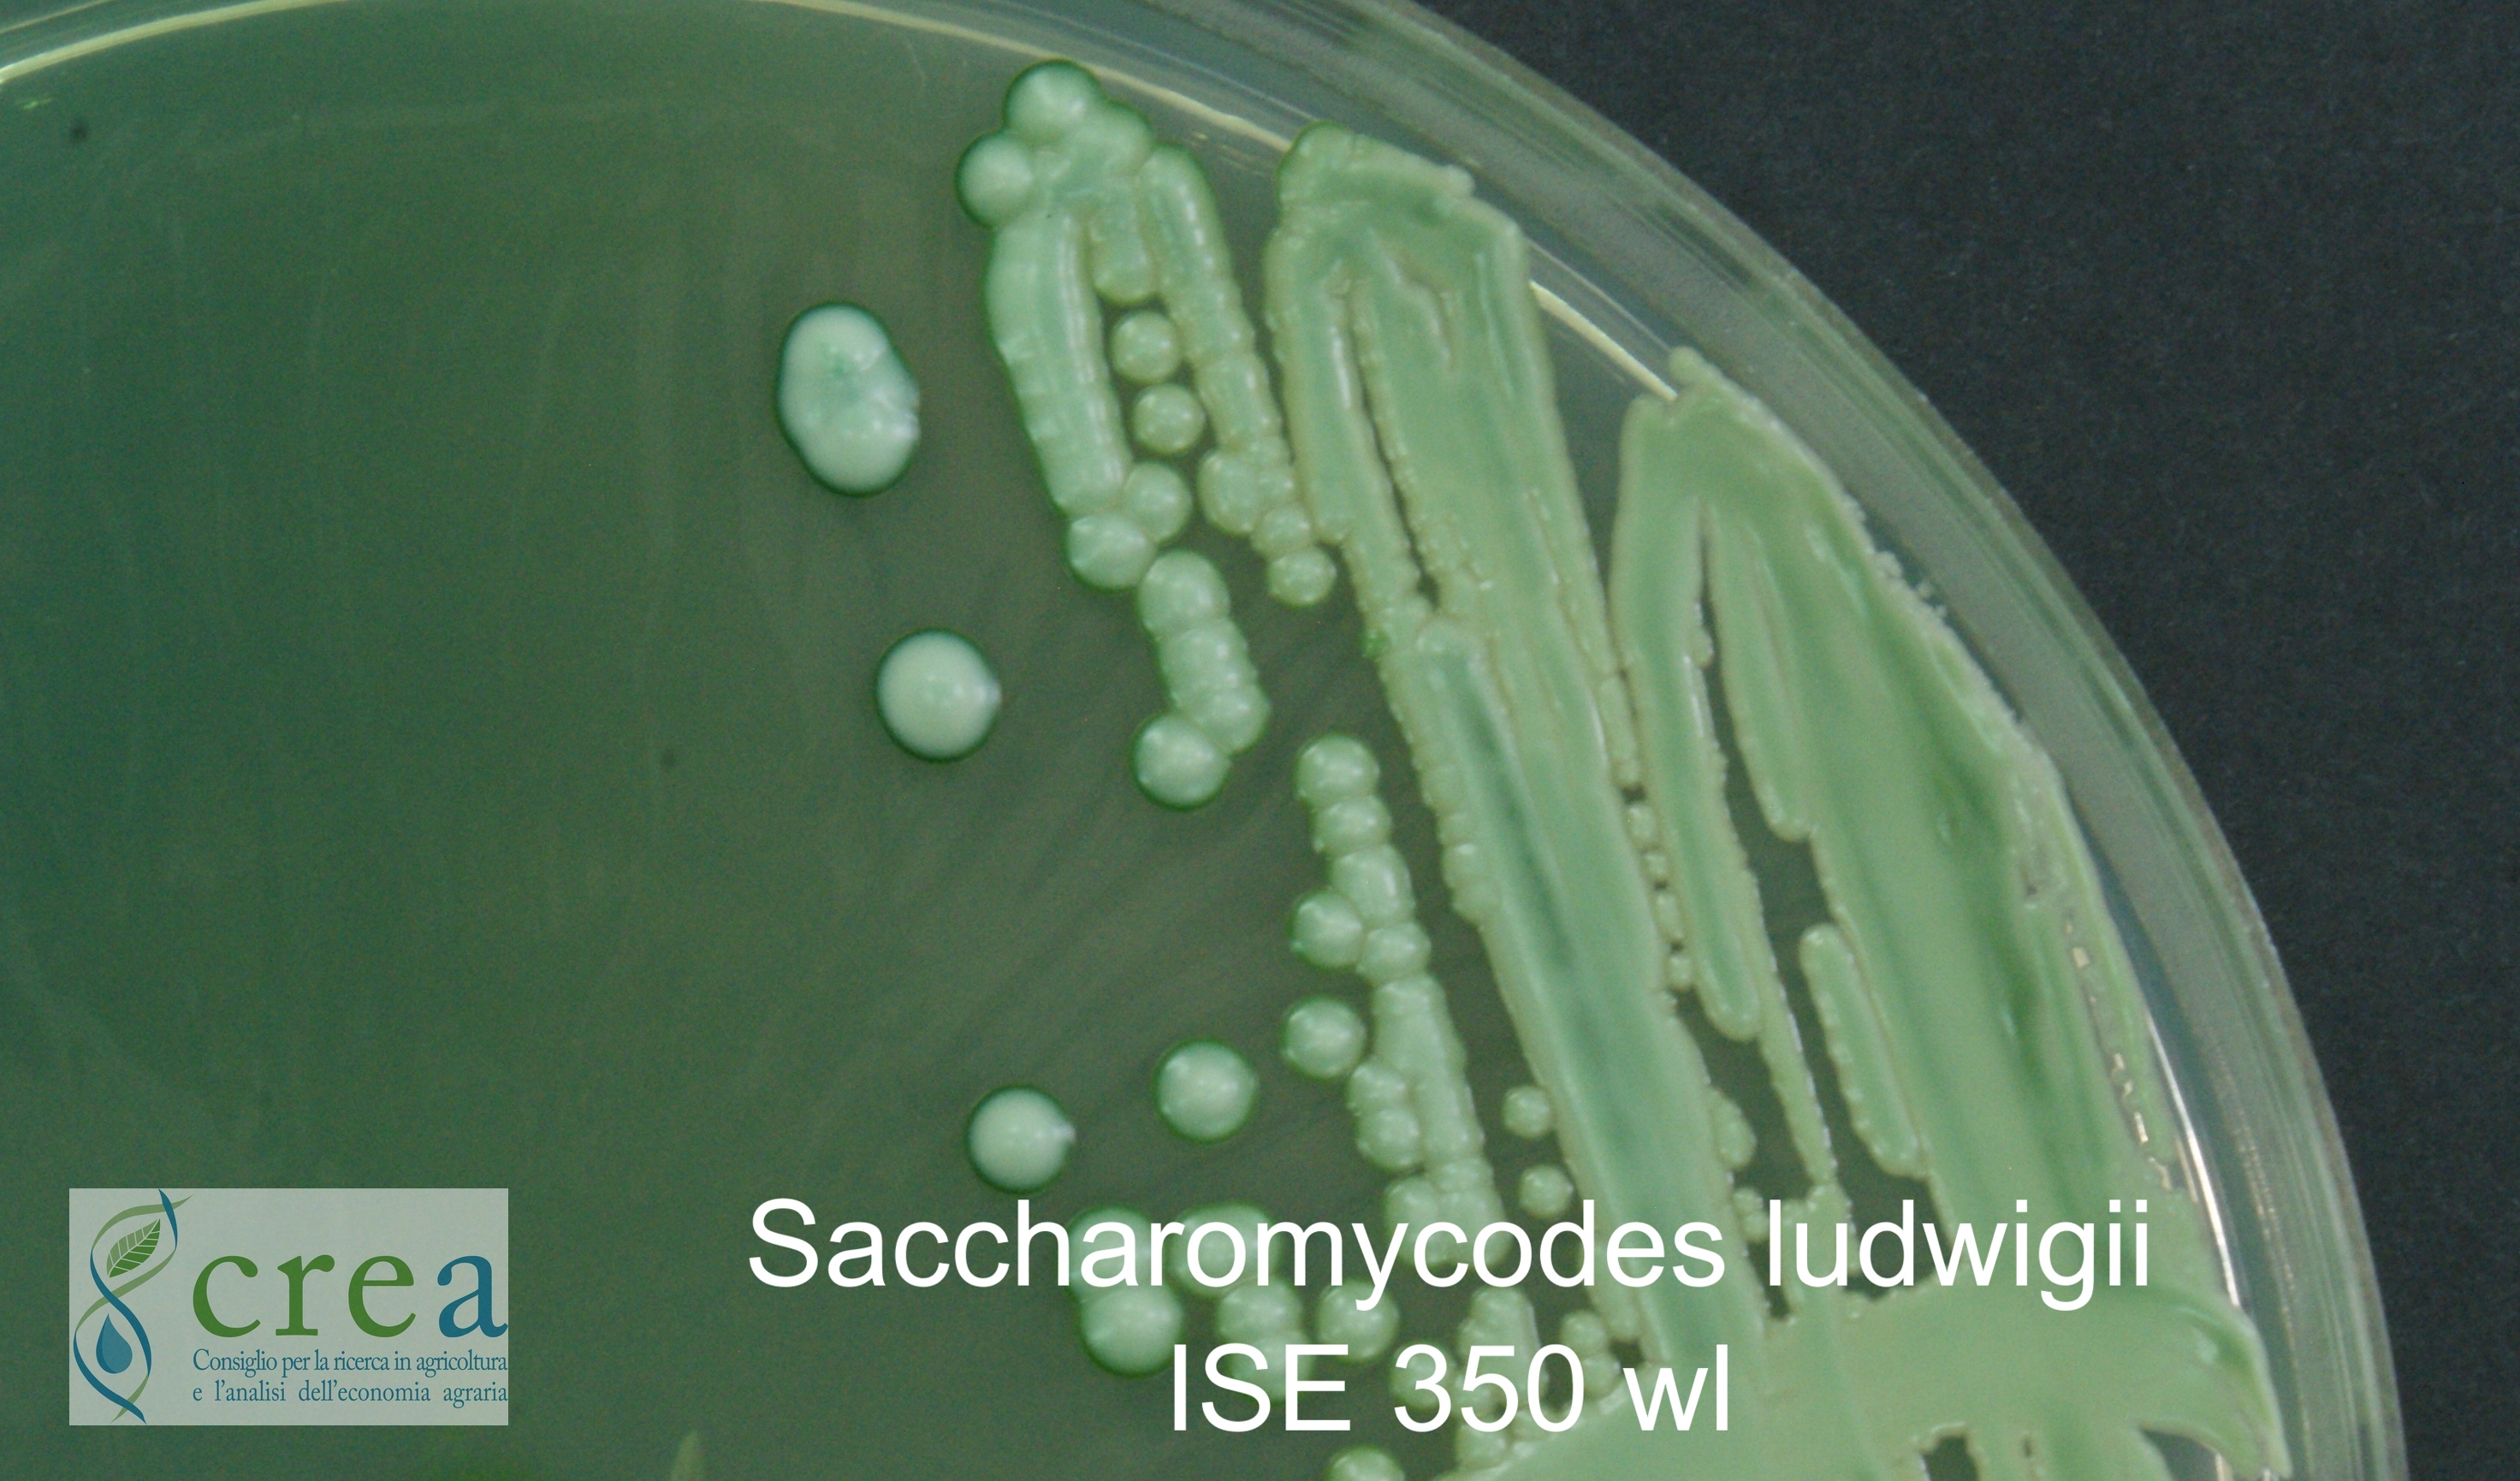
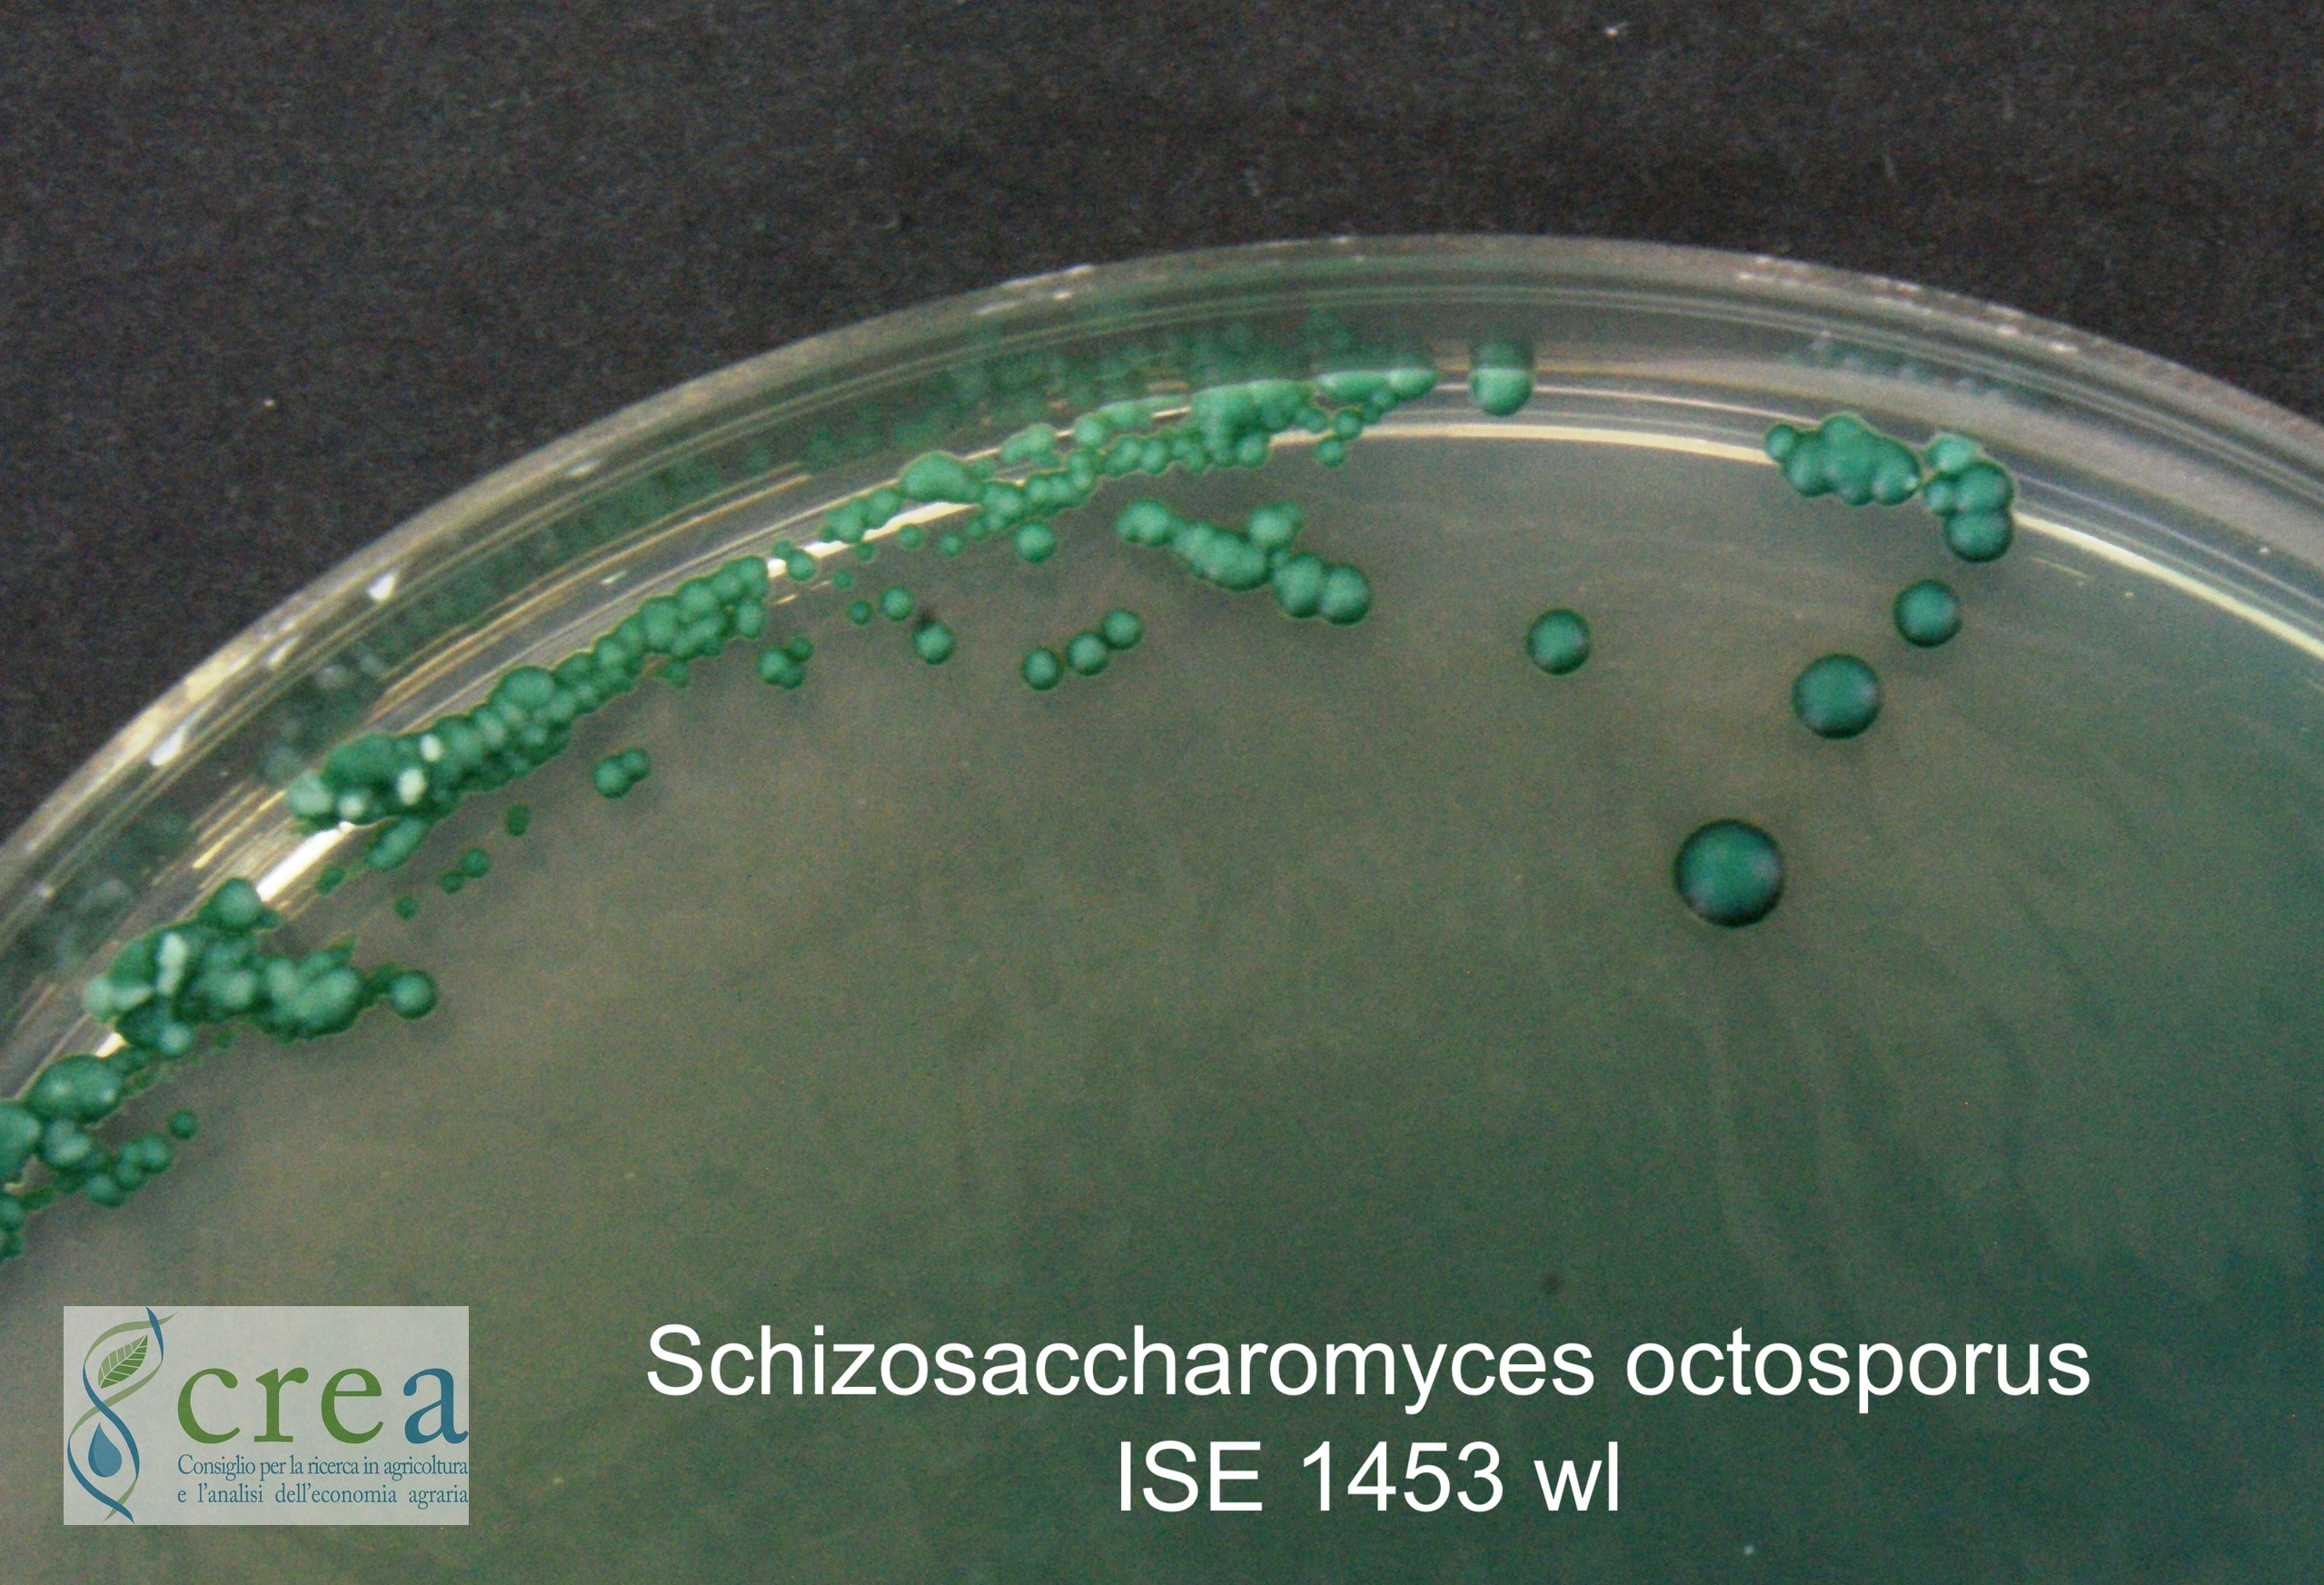
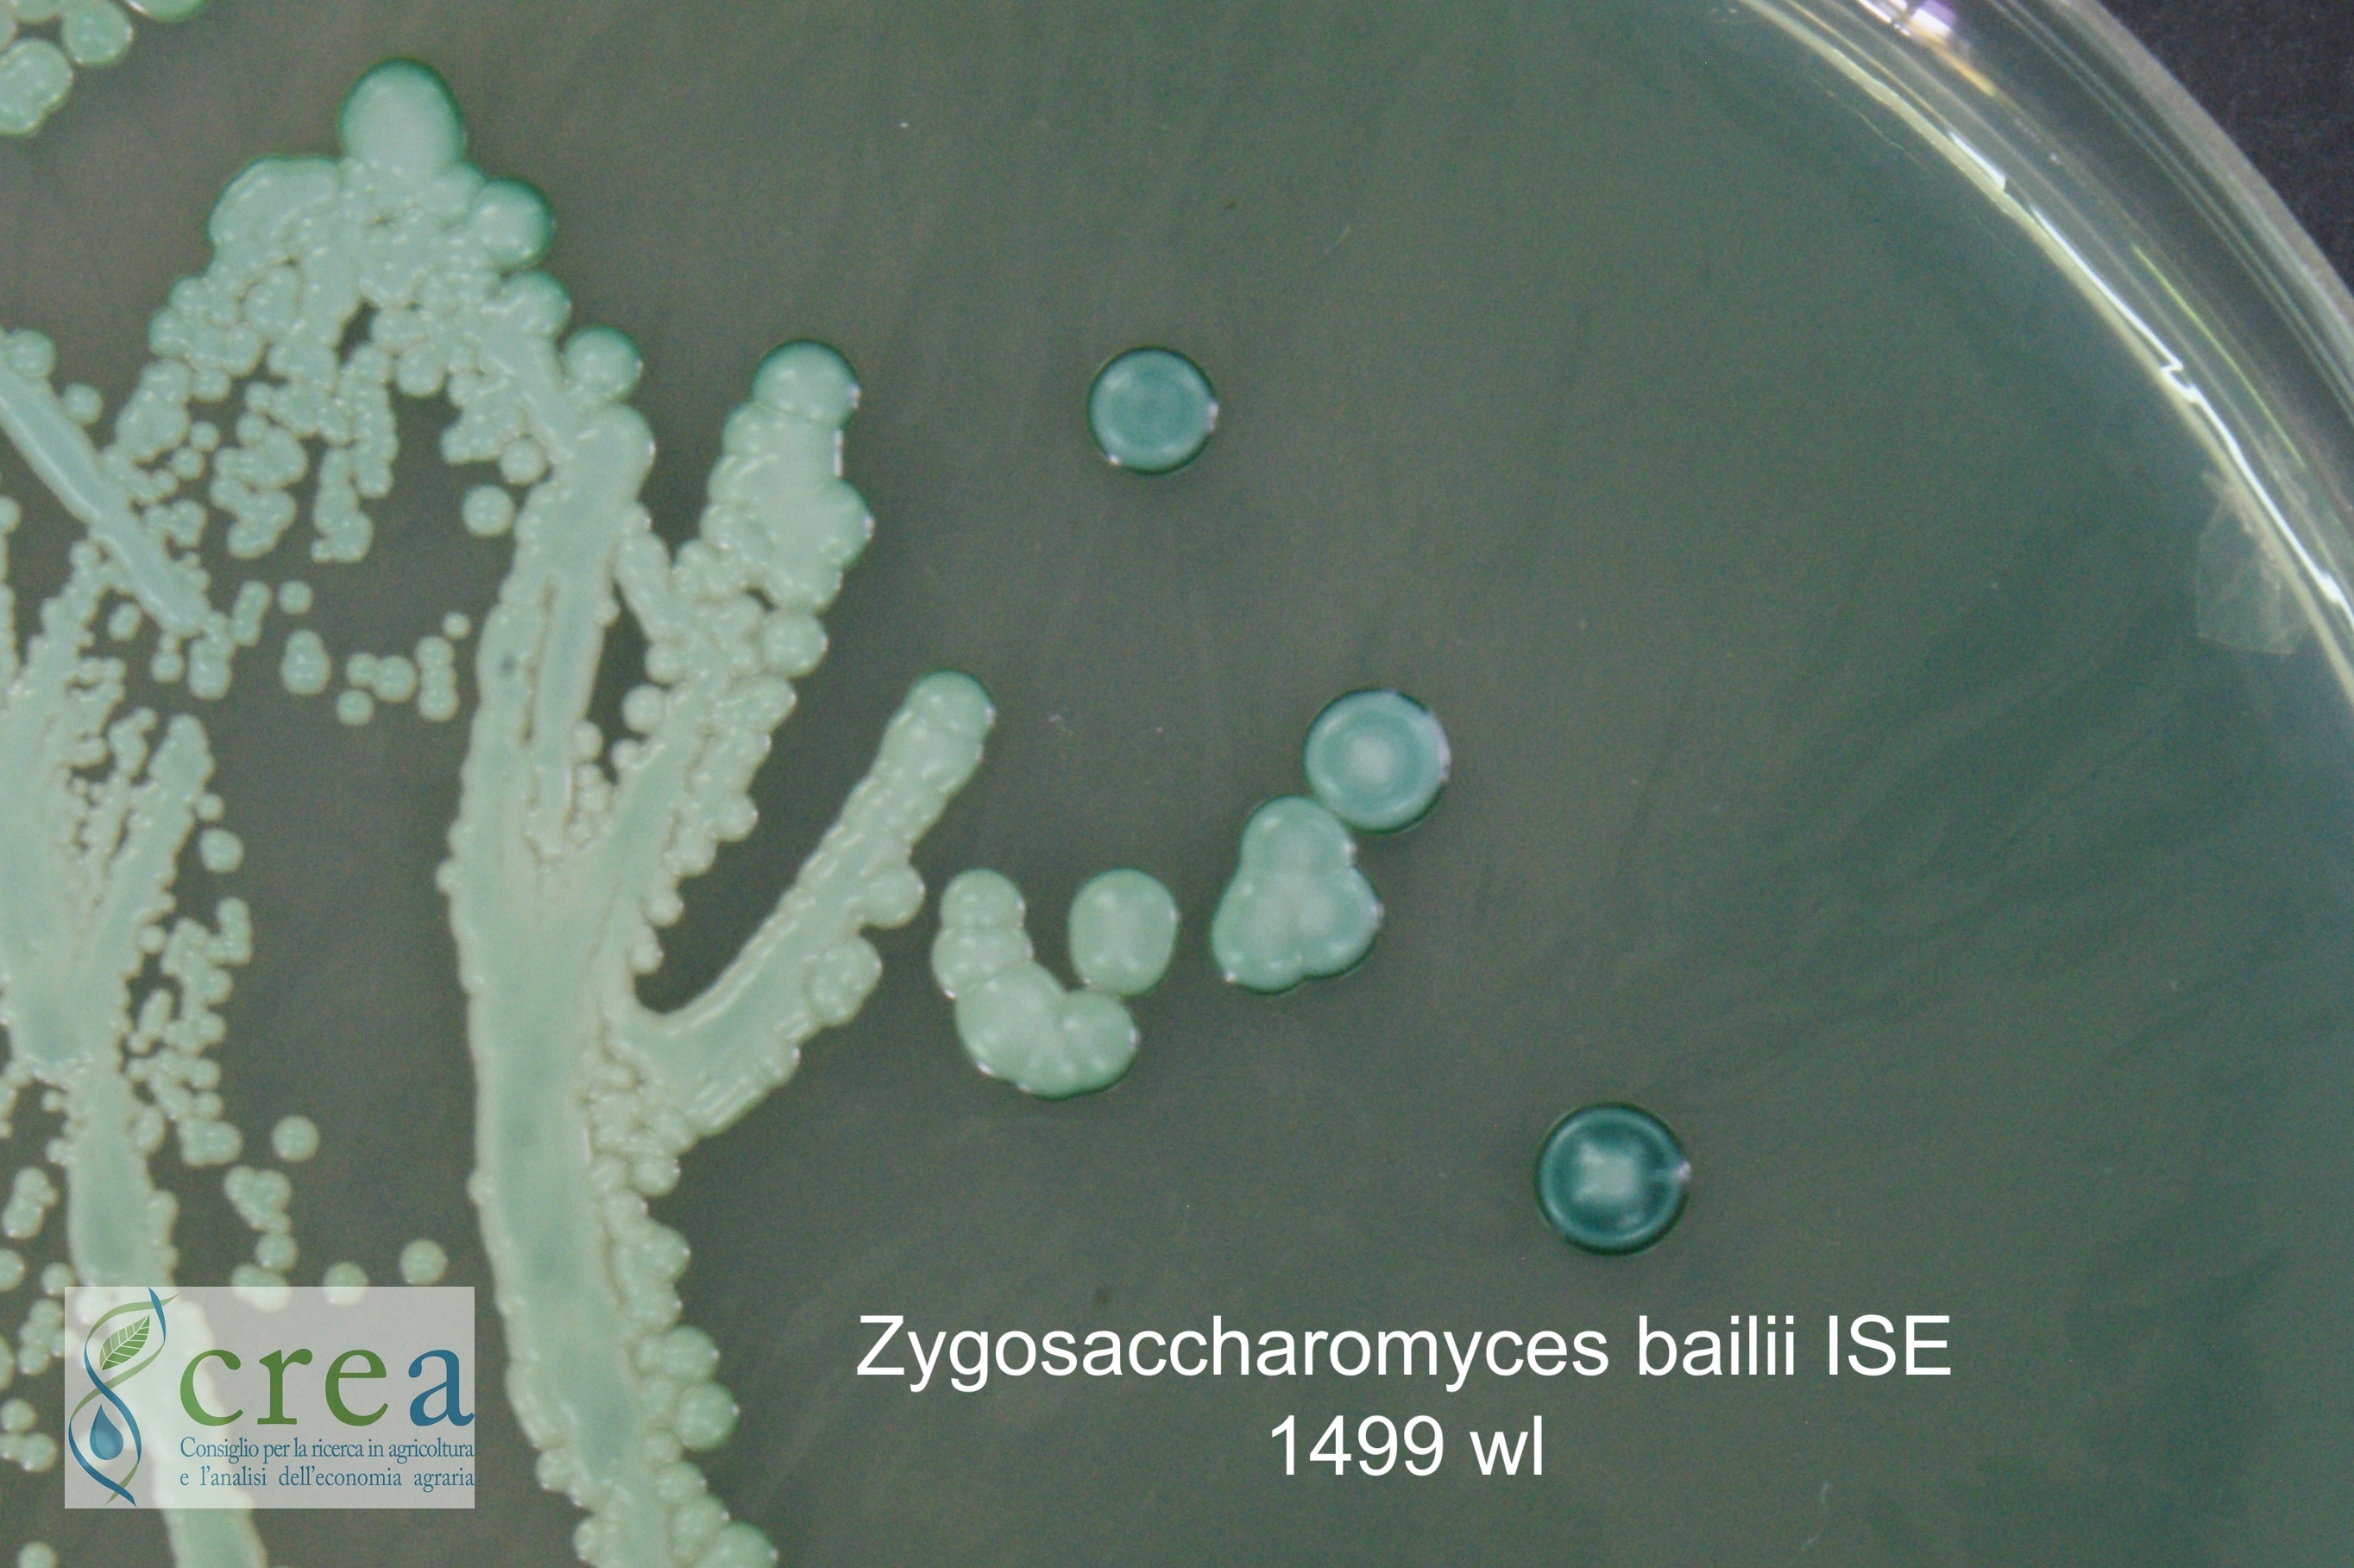

Aerobasidium pullulans ISE 1575 wl
Brettanomyces bruxellensis ISE 1496 wl
Candida californica ISE 1593 wl
Candida glabrata ISE 1498 wl
Candida guilliermondi ISE 311 wl
Candida stellata ISE 1509 wl
Kregervanrija fluxuum (ex Candida vini)ISE 1508 wl
Cryptococcus flavescens ISE 1577 wl
Curvibasidium cygneicollum ISE 1573 wl
Debaryomyces hansenii ISE 1504 wl
Hanseniaspora osmophila ISE 1339 wl
Hanseniaspora uvarum ISE 1507 wl
Kazachstania exigua ISE 1451 wl
Kloeckera corticis ISE 306 wl
Kluyveromyces thermotolerans ISE 1500 wl
Metschnikowia pulcherrima ISE 1502 wl
Meyerozyma carribica ISE 1580 wl
Pichia anomala ISE 340 wl
Pichia carsonii ISE 1503 wl
Pichia fermentans ISE 1513 wl
Pichia jadinii ISE 337 wl
Pichia kluyveri ISE 1604 wl
Pichia membranaefaciens ISE 1501 wl
Pichia petersonii ISE 339 wl
Rhodotorula babjevae ISE 1595 wl
Rhodotorula mucillaginosa ISE 1505 wl
Saccharomyces bayanus ISE 1449 wl
Saccharomyces cerevisiae ISE 1450 wl
Saccharomyces cerevisiae ISE 1571 wl
Saccharomyces paradoxus ISE 1618 wl
Saccharomycodes ludwigii ISE 350 wl
Schizosaccharomyces japonicus ISE 1452 wl
Schizosaccharomyces octosporus ISE 1453 wl
Schizosaccharomyces pombe ISE 1454 wl
Starmerella bacillaris ISE 1511 wl
Torulaspora delbrueckii ISE 1448 wl
Zygosaccaromyces bailii ISE 1499 wl
Zygosaccharomyces bisporus ISE 1447 wl
Zygosaccharomyces florentinus ISE 1460 wl